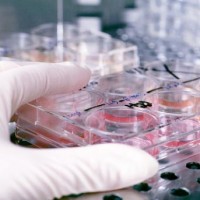

Sebuah penelitian terbaru menunjukkan bahwa bagi mereka yang berusia tua, minyak ikan dapat membantu menjaga kesehatan jantung dengan cara mempengaruhi aktifitas elektrikalnya. Diketahui bahwa dua potong ikan yang mengandung asam lemak omega 3 yang dikonsumsi tiap minggunya, dengan cara dipanggang atau direbus, tetapi tidak digoreng, sangat baik untuk kesehatan jantung. Pernyataan tersebut telah dilaporkan dalam Journal of The American College of Cardiology.
Hasil penelitian ini didukung oleh penelitian lain yang juga menyimpulkan bahwa dengan membiasakan konsumsi ikan, maka akan dapat mengurangi risiko terjadinya kematian mendadak. Sebelumnya memang telah diketahui bahwa konsumsi ikan tuna, makarel, dan salmon merupakan jenis ikan yang kaya akan kandungan asam lemak omega 3, yang terbukti sangat berguna untuk jantung.
Penelitian ini dilakukan melalui analisis data terhadap lebih dari 5.000 pria dan wanita berusia 65 tahun atau lebih. Para partisipan tersebut diberi pertanyaan tentang kebiasaan makan mereka, misalnya ikan atau jenis makanan lainnya. Hasil jawaban tentang diet mereka kemudian dibandingkan dengan tes elektrokardiografi yang dilakukan pada setiap partisipan tersebut.
Para peneliti menjelaskan bahwa efek konsumsi ikan terhadap kesehatan jantung yaitu menurunkan frekuensi detak jantung, memperlambat interval antara saat jantung menerima sinyal untuk memompakan darah dan saat darah dipompakan, serta membuat sistem elektrikal jantung lebih teratur kembali setelah sekali pompa.
Perlu diketahui, jantung akan selalu melakukan setting ulang terhadap aktifitas elektrikalnya setelah satu kali pompa. Bila terjadi gangguan di jantung, maka aktifitas untuk melakukan setting tersebut akan mengalami perlambatan dan akibatnya bisa berbahaya.
Meskipun tergolong keluarga minyak-minyakan, jenis minyak yang satu ini tidak digunakan untuk menggoreng kerupuk atau tahu. Namun merupakan sumber zat gizi.
Minyak ikan juga tergolong sebagai sumber lemak yang rendah kolesterol, sehingga para ahli gizi dan kesehatan sepakat bahwa minyak ikan aman untuk dikonsumsi oleh bayi, balita, orang dewasa serta ibu hamil.
Mengapa menyehatkan?
Selain mengandung Omega-3, minyak ikan juga mengandung vitamin A, D, dan juga kalsium. Itu sebabnya minyak ikan baik untuk pertumbuhan tulang dan gigi pada balita. Minyak ikan mengandung vitamin D yang dapat meningkatkan selera makan.
Minyak ikan juga mengandung asam lemak tak jenuh ganda yang berfungsi untuk membantu proses tumbuh-kembang otak (kecerdasan), serta perkembangan indera penglihatan dan sistem kekebalan tubuh bayi dan balita. Sedangkan bagi ibu hamil, minyak ikan bermanfaat untuk meningkatkan kualitas kehamilan.
Jangan dikonsumsi berlebih
Meskipun manfaat minyak ikan sangat besar, dan baik bagi kesehatan, namun jangan dikonsumsi berlebih. Terlalu banyak mengonsumsi minyak ikan dapat menurunkan kadar vitamin E dalam tubuh.
Bila minyak ikan terbuat dari ekstrak hati ikan, kelebihan takaran dapat menyebabkan keracunan vitamin A dan vitamin D. Sebab, hati ikan adalah salah satu tempat menumpuknya zat-zat beracun. Apalagi, bila ikan tersebut tadinya hidup di tempat yang tidak memenuhi standar kesehatan dan tidak higienis.
Berapa jumlah yang disarankan?
Untuk bayi dan balita, konsumsi minyak ikan per harinya didasarkan pada berat badannya. Sebagai patokan adalah 1 sendok teh per hari bila berat badan anak Anda 10 kg. Jika berat badannya lebih dari 10 kg, gunakan alat takar berupa sendok makan, karena jumlah kebutuhannya juga akan meningkat.
Penyimpanan
Proses oksidasi lemak yang terkandung dalam minyak ikan, dapat terjadi sehingga merusak kualitas minyak ikan dan mengubah aromanya menjadi tengik. Sebaiknya simpan minyak ikan di dalam wadah yang tertutup rapat dan letakkan di tempat yang sejuk
Cari Blog Ini
Rabu, 13 Oktober 2010
Berjuta Manfaat Cairan Dalam Tubuh
Air merupakan bagian terbesar dalam tubuh manusia dan hampir semua reaksi di dalam tubuh memerlukan cairan. Bila konsumsi air sangat sedikit, maka reaksi yang terjadi di dalam tubuh akan terganggu. Oleh sebab itu, tubuh harus mendapatkan masukan cairan setiap hari untuk menggantikan cairan yang hilang agar metabolismenya dapat berlangsung dengan normal.
Umumnya kehilangan air terjadi melalui paru-paru, kulit, saluran pencernaan, dan ginjal. Kehilangan cairan yang normal berlangsung akibat pemakaian energi. Sedangkan kehilangan cairan yang abnormal terjadi akibat berbagai penyakit atau keadaan yang tak normal, seperti suhu lingkungan yang tinggi, berkeringat, atau akibat berbagai penyakit. Pengeluaran cairan yang banyak dari tubuh tanpa diimbangi dengan konsumsi cairan akan mengakibatkan dehidrasi.
Mengatur suhu tubuh
Air berfungsi untuk mengatur suhu tubuh. Bila kekurangan air, suhu tubuh akan menjadi panas dan naik. Jika berada pada daerah yang suhunya panas, tubuh kita membutuhkan air yang cukup.
Melancarkan darah
Air juga berfungsi untuk melancarkan peredaran darah. Bila tubuh kita kekurangan cairan, maka darah akan menjadi lebih mengental. Keadaan tersebut disebabkan cairan dalam darah tersedot untuk kebutuhan tubuh dan akhirnya dapat mempengaruhi kinerja otak dan jantung.
Membuang racun dan sisa makanan
Kecukupan air di dalam tubuh akan membantu mengeluarkan racun dari dalam tubuh. Air akan membersihkan racun di dalam tubuh melalui keringat, air seni, dan pernapasan. Selain itu, air juga akan membersihkan sisa-sisa makanan yang tidak diperlukan oleh tubuh melalui ginjal.
Kulit
Air sangat penting untuk mengatur struktur dan fungsi kulit. Bila kekurangan air, kulit akan terlihat lebih kusam, kasar, berkerut, dan tidak segar. Kecukupan air di dalam tubuh diperlukan untuk menjaga kelembaban, kelembutan, dan elastilitas kulit akibat pengaruh udara panas dari luar tubuh.
Pencernaan
Peran air di dalam tubuh sangat vital untuk proses pencernaan yaitu sebagai pengangkut nutrisi dan oksigen melalui darah dan segera mengirimkannya ke sel-sel tubuh. Konsumsi air yang cukup akan membantu kerja sistem pencernaan dalam usus besar sehingga mencegah konstipasi.
Pernapasan
Paru-paru juga memerlukan air untuk pernapasan. Paru-paru kita harus basah dalam bekerja memasukkan oksigen ke dalam sel tubuh dan memompakan karbondioksida ke luar tubuh.
Sendi dan otot
Kecukupan air akan melindungi dan melumasi gerakan sendi dan otot. Oleh sebab itu, konsumsi air selama beraktivitas cukup penting untuk meminimalkan risiko kejang otot dan kelelahan.
Pemulihan penyakit
Air juga mendukung proses pemulihan. Asupan air yang cukup ketika kita sedang sakit berguna untuk meredakan demam dan mengganti cairan tubuh yang terbuang
Air adalah salah satu unsur dominan dalam tubuh manusia. Sekitar 60-70 persen tubuh manusia terdiri dari cairan. Maka, tubuh sangat butuh cairan. Air
putih memiliki banyak manfaat bagi tubuh. Berikut tujuh manfaat air putih bagi tubuh.
1. Menurunkan berat badan
Air putih membantu merasa kenyang dan melancarkan metabolisme. Ganti minuman soda atau manis yang sarat kalori dengan air. Minumlah air putih sebelum makan untuk membantu merasa lebih kenyang. Terutama jika minum minuman dingin. Tubuh harus bekerja untuk menghangatkan air. Ini akan membakar kalori lebih banyak daripada air biasa.
2. Meningkatkan Energi
Jika anda merasa lelah, pulihkanlah dengan air. Dehidrasi alias kekurangan cairan membuat tubuh merasa lelah. Air membantu transportasi oksigen darah dan nutrisi penting lainnya ke sel-sel tubuh. Jika tubuh cukup air, jantung kerja lebih santai untuk memompa darah ke seluruh tubuh.
3. Menurunkan stres
Sebagian besar otak adalah air. Sebanyak 85 persen dari jaringan otak terdiri dari air. Jika kekurangan air, tubuh dan pikiran akan stres. Jika anda merasa haus, artinya anda sudah sedikit dehidrasi. Siapkanlah selalui air, untuk mencegah stres.
4. Membangun Otot
Minum air membantu mencegah kram otot. Air menjadi pelumas bagi sendi dalam tubuh. Bila tubuh cukup cairan, Anda bisa berolah raga lebih lama dan lebih berat.
5. Memelihara Kulit
Garis-garis halus dan kerutan akan lebih jelas ketika tubuh kekurangan cairan.
Air adalah krim alami untuk kecantikan sendiri. Minum air akan memperbaiki sel-sel kulit dan membuat wajah tampak lebih muda. Air juga mengeluarkan kotoran dan meningkatkan sirkulasi dan aliran darah. Sehingga meninggalkan wajah bersih dan bercahaya.
6. Membantu pencernaan
Selain serat, air sangat penting untuk pencernaan yang baik.
Air membantu melarutkan partikel limbah dan memprosesnya dengan lancar melalui saluran pencernaan Anda.
Jika tubuh dehidrasi, tubuh menyerap semua air, membuat usus besar jadi kering dan membuat partikel limbah susah diproses.
7. Melarutkan Batu Ginjal
Batu ginjal akan meningkat apabila tubuh tak cukup minum cukup air. Air berguna mencairkan garam dan mineral dalam urin yang membentuk kristal padat yang dikenal sebagai batu ginjal.
Batu ginjal tidak dapat terbentuk dalam urin, jika tubuh cukup air. Dengan cukup air, resiko terkena batu ginjal akan berkurang.
Umumnya kehilangan air terjadi melalui paru-paru, kulit, saluran pencernaan, dan ginjal. Kehilangan cairan yang normal berlangsung akibat pemakaian energi. Sedangkan kehilangan cairan yang abnormal terjadi akibat berbagai penyakit atau keadaan yang tak normal, seperti suhu lingkungan yang tinggi, berkeringat, atau akibat berbagai penyakit. Pengeluaran cairan yang banyak dari tubuh tanpa diimbangi dengan konsumsi cairan akan mengakibatkan dehidrasi.
Mengatur suhu tubuh
Air berfungsi untuk mengatur suhu tubuh. Bila kekurangan air, suhu tubuh akan menjadi panas dan naik. Jika berada pada daerah yang suhunya panas, tubuh kita membutuhkan air yang cukup.
Melancarkan darah
Air juga berfungsi untuk melancarkan peredaran darah. Bila tubuh kita kekurangan cairan, maka darah akan menjadi lebih mengental. Keadaan tersebut disebabkan cairan dalam darah tersedot untuk kebutuhan tubuh dan akhirnya dapat mempengaruhi kinerja otak dan jantung.
Membuang racun dan sisa makanan
Kecukupan air di dalam tubuh akan membantu mengeluarkan racun dari dalam tubuh. Air akan membersihkan racun di dalam tubuh melalui keringat, air seni, dan pernapasan. Selain itu, air juga akan membersihkan sisa-sisa makanan yang tidak diperlukan oleh tubuh melalui ginjal.
Kulit
Air sangat penting untuk mengatur struktur dan fungsi kulit. Bila kekurangan air, kulit akan terlihat lebih kusam, kasar, berkerut, dan tidak segar. Kecukupan air di dalam tubuh diperlukan untuk menjaga kelembaban, kelembutan, dan elastilitas kulit akibat pengaruh udara panas dari luar tubuh.
Pencernaan
Peran air di dalam tubuh sangat vital untuk proses pencernaan yaitu sebagai pengangkut nutrisi dan oksigen melalui darah dan segera mengirimkannya ke sel-sel tubuh. Konsumsi air yang cukup akan membantu kerja sistem pencernaan dalam usus besar sehingga mencegah konstipasi.
Pernapasan
Paru-paru juga memerlukan air untuk pernapasan. Paru-paru kita harus basah dalam bekerja memasukkan oksigen ke dalam sel tubuh dan memompakan karbondioksida ke luar tubuh.
Sendi dan otot
Kecukupan air akan melindungi dan melumasi gerakan sendi dan otot. Oleh sebab itu, konsumsi air selama beraktivitas cukup penting untuk meminimalkan risiko kejang otot dan kelelahan.
Pemulihan penyakit
Air juga mendukung proses pemulihan. Asupan air yang cukup ketika kita sedang sakit berguna untuk meredakan demam dan mengganti cairan tubuh yang terbuang
Air adalah salah satu unsur dominan dalam tubuh manusia. Sekitar 60-70 persen tubuh manusia terdiri dari cairan. Maka, tubuh sangat butuh cairan. Air
putih memiliki banyak manfaat bagi tubuh. Berikut tujuh manfaat air putih bagi tubuh.
1. Menurunkan berat badan
Air putih membantu merasa kenyang dan melancarkan metabolisme. Ganti minuman soda atau manis yang sarat kalori dengan air. Minumlah air putih sebelum makan untuk membantu merasa lebih kenyang. Terutama jika minum minuman dingin. Tubuh harus bekerja untuk menghangatkan air. Ini akan membakar kalori lebih banyak daripada air biasa.
2. Meningkatkan Energi
Jika anda merasa lelah, pulihkanlah dengan air. Dehidrasi alias kekurangan cairan membuat tubuh merasa lelah. Air membantu transportasi oksigen darah dan nutrisi penting lainnya ke sel-sel tubuh. Jika tubuh cukup air, jantung kerja lebih santai untuk memompa darah ke seluruh tubuh.
3. Menurunkan stres
Sebagian besar otak adalah air. Sebanyak 85 persen dari jaringan otak terdiri dari air. Jika kekurangan air, tubuh dan pikiran akan stres. Jika anda merasa haus, artinya anda sudah sedikit dehidrasi. Siapkanlah selalui air, untuk mencegah stres.
4. Membangun Otot
Minum air membantu mencegah kram otot. Air menjadi pelumas bagi sendi dalam tubuh. Bila tubuh cukup cairan, Anda bisa berolah raga lebih lama dan lebih berat.
5. Memelihara Kulit
Garis-garis halus dan kerutan akan lebih jelas ketika tubuh kekurangan cairan.
Air adalah krim alami untuk kecantikan sendiri. Minum air akan memperbaiki sel-sel kulit dan membuat wajah tampak lebih muda. Air juga mengeluarkan kotoran dan meningkatkan sirkulasi dan aliran darah. Sehingga meninggalkan wajah bersih dan bercahaya.
6. Membantu pencernaan
Selain serat, air sangat penting untuk pencernaan yang baik.
Air membantu melarutkan partikel limbah dan memprosesnya dengan lancar melalui saluran pencernaan Anda.
Jika tubuh dehidrasi, tubuh menyerap semua air, membuat usus besar jadi kering dan membuat partikel limbah susah diproses.
7. Melarutkan Batu Ginjal
Batu ginjal akan meningkat apabila tubuh tak cukup minum cukup air. Air berguna mencairkan garam dan mineral dalam urin yang membentuk kristal padat yang dikenal sebagai batu ginjal.
Batu ginjal tidak dapat terbentuk dalam urin, jika tubuh cukup air. Dengan cukup air, resiko terkena batu ginjal akan berkurang.
Minum Kopi Atasi Penyakit Kronis
KOMPAS.com - Hasil penelitian terbaru menunjukkan, konsumsi kopi efektif mengatasi berbagai penyakit kronis. Namun untuk mencapai manfaat yang dimaksud, konsumsi kopi tidak boleh sembarangan dan harus berkualitas baik dan asli.
Surip Mawardi, peneliti kopi dan kakao Indonesia di sela-sela Konferensi Internasional Ilmu Pengetahuan Kopi 2010 di Nusa Dua Bali menyatakan, berdasarkan hasil penelitian terbaru, kopi bisa mengatasi berbagai macam penyakit seperti diabetes, kanker usus bahkan jantung koroner.
Dari hasil penelitian terbaru itu, lanjutnya, terungkap juga bahwa minum kopi seumur hidup memberikan efek yang menetralkan kesehatan jantung bagi peminumnya.
“Hal itu berdasarkan data metaanalisa terbaru terhadap 21 penelitian kohort prospektif yang dilakukan dari 1996 sampai 2008 dengan total kasus sebanyak 15.559 dengan melibatkan 407.806 sukarelawan untuk objek penelitian,” ujarnya menjelaskan.
Dikatakan, hasil penelitian juga menunjukkan bahwa tingkat konsumsi minum kopi tidak mengubah risiko perkembangan penyakit jantung koroner. “Bahkan dengan mengkonsumsi kopi kurang dari dua cangkir per hari bisa mengurangi derita penyakit jantung koroner,” terangnya.
Hasil penelitian tersebut, kata Surip, bisa mementahkan dugaan yang selama ini menilai bahwa minum kopi merusak kesehatan, terutama sistim jantung dan kardiovaskular.
Di sisi lain, Surip mengatakan, pendekatan penelitian yang umum dilakukan oleh para peneliti adalah mempelajari pengaruh suatu komponen tunggal dalam kopi terhadap kesehatan peminumnya. Kemudian mereka menarik kesimpulan dari data yang diperoleh dengan menggunakan senyawa tunggal tersebut.
Perlu diketahui, lanjutnya, kopi merupakan minuman mengandung senyawa yang sangat kompleks, terdiri lebih dari 800 komponen yang berbeda dan saling berinteraksi dalam jenis senyawa yang berdiri sendiri.
“Saat ini, banyak bukti medis dan ilmiah yang mendukung kesimpulan bahwa minum kopi dengan porsi normal antara dua sampai empat cangkir per hari dengan kandungan kafein sampai dengan 100 miligram per cangkir, merupakan bagian dari pola makan yang berimbang,” katanya.
Kehebatan Daun Pisang untuk Para Korban Luka Bakar
Anda mendapati keluarga, kerabat atau tetangga yang tubuhnya tebakar hebat? Jangan panik. Siapkan handuk basah dan daun pisang yang bersih, sebagai langkah darurat yang bisa mencegah korban kebakaran mengalami dehidrasi, dan berakhir dengan kematian.
Menurut A. Gore dan Deepika Madhori Akolekar dalam jurnal ilmiah Evaluasi dari Banana Leaf Dressing untuk Partical Luka daun pisang memiliki banyak keuntungan dalam penggunaannya dalam luka bakar. daun pisang mengurangi penguapan cairan karena ada lapisan lilin.
Daun pisang juga menciptakan sensasi dingin pada kulit tubuh, tidak melekat pada luka, dan memiliki permukaan yang luas sehingga bisa mencakup semua bagian tubuh.
Dalam penelitian yang dilakukan oleh Evi Rohmatun berjudul Sifat-sifat Fisik dan Efek Salep Ekstrak Daun Muda Pisang (Musa paradisiaca, Linn) Terhadap Penyembuhan Luka Bakar pada Kulit, daun pisang muda ekstrak membantu penyembuhan luka bakar dengan hasil yang signifikan.
Banyak orang dengan korban kebakaran atau sengatan listrik telah mati ketika mereka tiba di rumah sakit. Hal utama yang dilakukan dalam menangani luka bakar yang luas adalah koreksi cairan tubuh dan pencegahan infeksi.
Mereka yang menderita luka bakar yang luas, biasanya lari ke mana saja untuk mencari bantuan. Situasi ini menyebabkan tubuh akan terkena oleh angin dan penguapan cairan tubuh semakin besar, yang akan berakhir dengan dehidrasi.
Oleh karena itu, jika ada saudara, teman, atau keluarga yang menderita luka bakar yang luas akibat kebakaran, lebih baik untuk menyarankan dia atau tinggal di tempat Jangan biarkan mereka dalam keadaan terbuka. Gunakan selimut basah untuk menutupi dirinya. Tutupi tubuhnya dengan daun pisang yang telah dibersihkan dengan alkohol dan NaCl dan membawanya langsung ke rumah sakit terdekat untuk mendapatkan koreksi cairan dan pencegahan infeksi.
Daun pisang bukan hanya untuk membungkus kueh, gudeg dan nasi uduk, tapi juga untuk membungkus korban kebakaran atau bagian tubuh yang terkena luka bakar.
Deman Q, Penyakit Serius Dengan Gejala Mirip Flu
Q fever atau demam Q disebabkan oleh jenis bakteri khusus yang dibawa oleh binatang, umumnya biri-biri, kambing dan hewan ternak. Jika anda menghirup udara dengan partikel debu yang terkontaminasi dengan hewan terinfeksi, Anda akan ikut terinfeksi.
Sebagian besar orang dengan demam Q umumnya tak menunjukkan gejala, namun sebagian lain merasakan gejala mirip flu, mengalami pneumonia atau hepatitis. Bentuk akut dari demam Q dapat menuntun pada demam Q kronis, di mana penyakit serius ini dapat bertahan dalam tiga hingga empat tahun, berdampak pada hati, jantung, otak dan paru-paru, seringkali berakibat fatal.
Demam Q akut umumnya akan sembuh dengan sendirinya dalam beberapa minggu tanpa pengobatan. Jika anda menderita gejala ini, dokter umumnya akan meresepkan antibiotik. Demam Q kronis membutuhkan terapi antibiotik khusus, diikuti dengan berbagai tes lain, hingga kemungkinan operasi. Gejala
Tanda-tanda dan gejala demam Q sangat bervariasi. Orang dengan demam akut Q mungkin tidak mempunyai gejala sama sekali, sementara kronis Q demam biasanya mempengaruhi jantung dan organ-organ utama lainnya.
Lebih dari separuh dari orang yang terinfeksi demam akut Q tidak pernah menunjukkan gejala. Jika seserang memiliki gejala-gejala, anda akan melihat mereka sekitar dua sampai tiga minggu setelah terkena bakteri. Infeksi dapat menyerupai flu, menyebabkan tanda-tanda dan gejala:
* Demam tinggi (104 derajat Fahrenheit, atau 40 derajat Celcius)
* Sakit kepala
* Kelelahan
* Sakit tenggorokan
* Menggigil
* Berkeringat
* Batuk, yang mungkin kering atau produktif
* Sakit perut
* Mual
* Muntah
* Diare
* Nyeri otot yang parah
Perawatan
Pengobatan untuk demam Q tergantung pada apakah infeksi akut atau kronis dan apakah penderita sedang hamil. Kasus demam akut Q sering menjadi lebih baik dalam waktu sekitar dua minggu tanpa pengobatan. Namun, meski tidak memiliki gejala, dokter tetap memberikan pengobatan untuk mencegah komplikasi.
Sebagian besar orang dengan demam Q umumnya tak menunjukkan gejala, namun sebagian lain merasakan gejala mirip flu, mengalami pneumonia atau hepatitis. Bentuk akut dari demam Q dapat menuntun pada demam Q kronis, di mana penyakit serius ini dapat bertahan dalam tiga hingga empat tahun, berdampak pada hati, jantung, otak dan paru-paru, seringkali berakibat fatal.
Demam Q akut umumnya akan sembuh dengan sendirinya dalam beberapa minggu tanpa pengobatan. Jika anda menderita gejala ini, dokter umumnya akan meresepkan antibiotik. Demam Q kronis membutuhkan terapi antibiotik khusus, diikuti dengan berbagai tes lain, hingga kemungkinan operasi. Gejala
Tanda-tanda dan gejala demam Q sangat bervariasi. Orang dengan demam akut Q mungkin tidak mempunyai gejala sama sekali, sementara kronis Q demam biasanya mempengaruhi jantung dan organ-organ utama lainnya.
Lebih dari separuh dari orang yang terinfeksi demam akut Q tidak pernah menunjukkan gejala. Jika seserang memiliki gejala-gejala, anda akan melihat mereka sekitar dua sampai tiga minggu setelah terkena bakteri. Infeksi dapat menyerupai flu, menyebabkan tanda-tanda dan gejala:
* Demam tinggi (104 derajat Fahrenheit, atau 40 derajat Celcius)
* Sakit kepala
* Kelelahan
* Sakit tenggorokan
* Menggigil
* Berkeringat
* Batuk, yang mungkin kering atau produktif
* Sakit perut
* Mual
* Muntah
* Diare
* Nyeri otot yang parah
Perawatan
Pengobatan untuk demam Q tergantung pada apakah infeksi akut atau kronis dan apakah penderita sedang hamil. Kasus demam akut Q sering menjadi lebih baik dalam waktu sekitar dua minggu tanpa pengobatan. Namun, meski tidak memiliki gejala, dokter tetap memberikan pengobatan untuk mencegah komplikasi.
Dampak Negatif Memangku Laptop
Tak sedikit orang yang terbiasa menggunakan pahanya sebagai pengganti meja untuk menaruh laptop. Meski praktis, waspadai gangguan kulit yang timbul akibat panas yang muncul dari komputer jinjing tersebut.
Meski rasa panas yang berasal dari mesin prosesor laptop tidak menyebabkan kulit terbakar, memangkunya bisa menyebabkan penggelapan warna kulit yang permanen atau disebut juga dengan istilah toasted skin syndrome. Meski jarang, kulit yang terpapar panas dari laptop juga bisa memicu kanker kulit.
Panas dari laptop bisa mencapai 50 derajat Celsius. Oleh karena itu, kita disarankan untuk tidak memangku laptop terlalu lama. Gangguan kulit merupakan salah satu dari 10 jenis dampak negatif penggunaan laptop bagi kesehatan yang dicatat para ahli.
Pada masa lalu, toasted skin syndrome biasanya diderita oleh para pekerja yang tugasnya berdekatan dengan sumber panas, seperti pekerja di pabrik roti atau pembuat kaca.
"Kulit yang gelap itu jika dilihat di bawah mikroskop mirip dengan kerusakan kulit akibat terlalu lama terpapar sinar matahari," kata dr Kimberley Salkey, profesor dermatologi dari Eastern Virginia Medical School, AS.
Laporan medis beberapa tahun lalu menunjukkan kasus seorang pria dengan temperatur di bagian skrotum atau buah zakarnya meningkat gara-gara terlalu sering memangku laptop. Dalam jangka panjang, hal ini akan menyebabkan produksi sel sperma berkurang sehingga menjadi infertil.
Hal yang paling mendasar bagi sebuah alat kerja seperti komputer adalah ketersediaan aliran listrik. Kondisi byarpet ataupun tegangan yang tidak stabil merupakan penyakit di negeri ini. Siapa pun pemimpinnya, dan tarif yang tidak pernah turun dengan alasan memperbaiki layanan, tetapi nyatanya persoalan masih tetap sama.
Persoalan kedua yang nyaris tidak pernah menjadi perhatian para pengguna alat kerja adalah masalah penerangan. Padahal, penerangan sangat berpengaruh besar pada kesehatan mata dan 80 persen informasi diperoleh dari indera penglihatan itu.
Kondisi penerangan ini diperparah dengan banyaknya lampu hemat energi yang sempat membanjiri pasar negeri ini. Memang murah meriah, tetapi karena tidak dirancang untuk kondisi perlistrikan di Indonesia, lampu-lampu itu mudah rusak, terutama bagian rangkaian elektronisnya.
Tidak adanya referensi tentang penerangan juga menjadi masalah bagi konsumen karena lampu yang tidak memenuhi standar membuat mata menjadi lelah. Matinya lampu pasti sangat merepotkan karena kebanyakan lampu dipasang di langit-langit rumah.
Sebuah klinik mata di Jakarta, yaitu Klinik Mata Nusantara, menyarankan penggunaan lampu yang menggunakan elektronik ballast. Perangkat ini mampu menghasilkan listrik berfrekuensi tinggi, di atas 20 kHz. Lampu dengan frekuensi rendah, sekitar 30 Hz sampai 70 Hz (listrik PLN 60 Hz), bisa menimbulkan kedipan yang melelahkan mata.
Meski rasa panas yang berasal dari mesin prosesor laptop tidak menyebabkan kulit terbakar, memangkunya bisa menyebabkan penggelapan warna kulit yang permanen atau disebut juga dengan istilah toasted skin syndrome. Meski jarang, kulit yang terpapar panas dari laptop juga bisa memicu kanker kulit.
Panas dari laptop bisa mencapai 50 derajat Celsius. Oleh karena itu, kita disarankan untuk tidak memangku laptop terlalu lama. Gangguan kulit merupakan salah satu dari 10 jenis dampak negatif penggunaan laptop bagi kesehatan yang dicatat para ahli.
Pada masa lalu, toasted skin syndrome biasanya diderita oleh para pekerja yang tugasnya berdekatan dengan sumber panas, seperti pekerja di pabrik roti atau pembuat kaca.
"Kulit yang gelap itu jika dilihat di bawah mikroskop mirip dengan kerusakan kulit akibat terlalu lama terpapar sinar matahari," kata dr Kimberley Salkey, profesor dermatologi dari Eastern Virginia Medical School, AS.
Laporan medis beberapa tahun lalu menunjukkan kasus seorang pria dengan temperatur di bagian skrotum atau buah zakarnya meningkat gara-gara terlalu sering memangku laptop. Dalam jangka panjang, hal ini akan menyebabkan produksi sel sperma berkurang sehingga menjadi infertil.
Hal yang paling mendasar bagi sebuah alat kerja seperti komputer adalah ketersediaan aliran listrik. Kondisi byarpet ataupun tegangan yang tidak stabil merupakan penyakit di negeri ini. Siapa pun pemimpinnya, dan tarif yang tidak pernah turun dengan alasan memperbaiki layanan, tetapi nyatanya persoalan masih tetap sama.
Persoalan kedua yang nyaris tidak pernah menjadi perhatian para pengguna alat kerja adalah masalah penerangan. Padahal, penerangan sangat berpengaruh besar pada kesehatan mata dan 80 persen informasi diperoleh dari indera penglihatan itu.
Kondisi penerangan ini diperparah dengan banyaknya lampu hemat energi yang sempat membanjiri pasar negeri ini. Memang murah meriah, tetapi karena tidak dirancang untuk kondisi perlistrikan di Indonesia, lampu-lampu itu mudah rusak, terutama bagian rangkaian elektronisnya.
Tidak adanya referensi tentang penerangan juga menjadi masalah bagi konsumen karena lampu yang tidak memenuhi standar membuat mata menjadi lelah. Matinya lampu pasti sangat merepotkan karena kebanyakan lampu dipasang di langit-langit rumah.
Sebuah klinik mata di Jakarta, yaitu Klinik Mata Nusantara, menyarankan penggunaan lampu yang menggunakan elektronik ballast. Perangkat ini mampu menghasilkan listrik berfrekuensi tinggi, di atas 20 kHz. Lampu dengan frekuensi rendah, sekitar 30 Hz sampai 70 Hz (listrik PLN 60 Hz), bisa menimbulkan kedipan yang melelahkan mata.
Dampak "Mengerikan" Alat Kesehatan, Dari Kanker Hingga Leukimia
Bila tidak terlalu diperlukan, para ahli menyarankan agar anak-anak tidak melakukan pemeriksaan sinar-X atau CT Scan. Radiasi dari alat-alat tersebut dalam waktu lama meningkatkan ancaman leukimia.
Alat-alat pemindai kesehatan, seperti sinar-X atau CT Scan memang bisa memberikan hasil tes medis secara cepat dan rinci. Beberapa penyakit pada anak seperti radang paru atau patah tulang juga membutuhkan alat-alat pemindai kesehatan untuk diagnosis yang lebih akurat.
Tetapi para ahli juga mengingatkan bahaya terselubung yang mungkin timbul. Pada anak-anak, paparan sinar-X tiga kali atau lebih akan meningkatkan ancaman leukimia. "Menghindari atau mengurangi paparan radiasi sangat penting," kata Patricia Buffler, dari Univesitas Berkeleys School of Public Health, Amerika.
Dalam penelitiannya, ia mengamati catatan medis 711 anak berusia maksimal 14 tahun yang didiagnosa leukimia limfoid akut di California antara tahun 1995-2008. Ia membandingkannya dengan data anak yang tidak menderita leukimia.
Secara umum peningkatan risiko leukimia pada anak memang tidak terlalu besar. Dari 100.000 anak, ada 4 yang terkena leukimia. Namun, meski kasus kankernya kecil, tetap saja risikonya ada. Buffler menjelaskan, radiasi yang terdapat dalam sinar-X membuat sel-sel dalam tubuh bermutasi dan menciptakan kanker. CT-Scan yang belakangan ini sangat populer memiliki tingkat radiasi yang lebih tinggi.
Pemajanan medan elektromagnet yang terlalu sering diduga meningkatkan risiko kanker. Demikian studi terbaru yang dipublikasikan dalam jurnal ilmiah New England Journal of Medicine.
Kesimpulan tersebut didapat berdasarkan survei terhadap 950.000 pasien. Hampir 70 persen pasien pernah mengalami sekurangnya satu kali prosedur pencitraan yang membuat mereka terpajan. Dalam waktu tiga tahun selanjutnya, diketahui mereka menderita kanker.
Secara teoritis, radiasi elektromagnetik berpotensi mengganggu kesehatan bila terpajan melampaui Nilai Ambang Batas Pemajanan. Leukimia, limfoma, kemandulan pada pria, cacat kongenital, proses degenaratif, perubahan ritme jantung, perubahan metabolisme melatonin, neurosis, merupakan contoh penyakit yang bisa ditimbulkan akibat pajanan ini (IDI, 1997).
Menurut para ahli, seharusnya pemeriksaan dengan pencitraan yang dilakukan lebih dari satu kali dilakukan bila manfaatnya lebih besar dari risikonya. Penelitian sebelumnya telah mengungkapkan banyak dokter yang memiliki fasilitas pencitraan meminta pasiennya melakukan pemeriksaan MRI, pemindaian CT 27 hingga 54 persen lebih banyak dibanding dokter lain yang tak memiliki fasilitas serupa.
Saat ini ada 3.500 izin penggunaan peralatan radiologi yang dikeluarkan oleh Badan Pengawas Tenaga Nuklir di seluruh Indonesia. Peralatan rontgen yang digunakan di seluruh Indonesia diperkirakan mencapai 6.000 unit. Oleh karena itu, pemerintah telah mengeluarkan peraturan mengenai dosis radiasi yang tepat bagi pasien.
Alat-alat pemindai kesehatan, seperti sinar-X atau CT Scan memang bisa memberikan hasil tes medis secara cepat dan rinci. Beberapa penyakit pada anak seperti radang paru atau patah tulang juga membutuhkan alat-alat pemindai kesehatan untuk diagnosis yang lebih akurat.
Tetapi para ahli juga mengingatkan bahaya terselubung yang mungkin timbul. Pada anak-anak, paparan sinar-X tiga kali atau lebih akan meningkatkan ancaman leukimia. "Menghindari atau mengurangi paparan radiasi sangat penting," kata Patricia Buffler, dari Univesitas Berkeleys School of Public Health, Amerika.
Dalam penelitiannya, ia mengamati catatan medis 711 anak berusia maksimal 14 tahun yang didiagnosa leukimia limfoid akut di California antara tahun 1995-2008. Ia membandingkannya dengan data anak yang tidak menderita leukimia.
Secara umum peningkatan risiko leukimia pada anak memang tidak terlalu besar. Dari 100.000 anak, ada 4 yang terkena leukimia. Namun, meski kasus kankernya kecil, tetap saja risikonya ada. Buffler menjelaskan, radiasi yang terdapat dalam sinar-X membuat sel-sel dalam tubuh bermutasi dan menciptakan kanker. CT-Scan yang belakangan ini sangat populer memiliki tingkat radiasi yang lebih tinggi.
Pemajanan medan elektromagnet yang terlalu sering diduga meningkatkan risiko kanker. Demikian studi terbaru yang dipublikasikan dalam jurnal ilmiah New England Journal of Medicine.
Kesimpulan tersebut didapat berdasarkan survei terhadap 950.000 pasien. Hampir 70 persen pasien pernah mengalami sekurangnya satu kali prosedur pencitraan yang membuat mereka terpajan. Dalam waktu tiga tahun selanjutnya, diketahui mereka menderita kanker.
Secara teoritis, radiasi elektromagnetik berpotensi mengganggu kesehatan bila terpajan melampaui Nilai Ambang Batas Pemajanan. Leukimia, limfoma, kemandulan pada pria, cacat kongenital, proses degenaratif, perubahan ritme jantung, perubahan metabolisme melatonin, neurosis, merupakan contoh penyakit yang bisa ditimbulkan akibat pajanan ini (IDI, 1997).
Menurut para ahli, seharusnya pemeriksaan dengan pencitraan yang dilakukan lebih dari satu kali dilakukan bila manfaatnya lebih besar dari risikonya. Penelitian sebelumnya telah mengungkapkan banyak dokter yang memiliki fasilitas pencitraan meminta pasiennya melakukan pemeriksaan MRI, pemindaian CT 27 hingga 54 persen lebih banyak dibanding dokter lain yang tak memiliki fasilitas serupa.
Saat ini ada 3.500 izin penggunaan peralatan radiologi yang dikeluarkan oleh Badan Pengawas Tenaga Nuklir di seluruh Indonesia. Peralatan rontgen yang digunakan di seluruh Indonesia diperkirakan mencapai 6.000 unit. Oleh karena itu, pemerintah telah mengeluarkan peraturan mengenai dosis radiasi yang tepat bagi pasien.
Dusta Tersembunyi Dibalik Ritual Diet
SAN FRANSISCO (Berita SuaraMedia) - Mintalah saran diet dari 10 orang, maka Anda akan mendapatkan 10 jawaban berbeda. Nyatanya, begitu banyak salah kaprah dalam urusan mengurangi bobot tubuh ini.
"Kebanyakan kita mengikuti aturan-aturan tertentu untuk bagaimana menghilangkan beberapa pon bagi seluruh hidup kita," kata Nancy Snyderman MD, editor NBC News dan penulis buku Diet Myths That Keep Us Fat.
"Tetapi banyak dari apa yang telah diberitahu kepada kita tentang berat badan, sebenarnya palsu," tegasnya.
Berikut, Snyderman membuka kebenaran untuk menyangkal mitos-mitos yang berkembang seputar diet hingga tubuh langsing mungkin Anda dapatkan, seperti dibeberkan Redbook.
Semakin Anda olahraga, semakin baik
Anda tahu bahwa olahraga merupakan salah satu hal terbaik untuk menjaga berat badan dan meningkatkan kesehatan secara keseluruhan, tapi olahraga berlebihan sebenarnya memiliki efek berlawanan.
"Bekerja tujuh hari sepekan dapat melemahkan sistem kekebalan tubuh, menegangkan sendi, dan melelahkan tubuh. Otot Anda perlu waktu untuk memperbaiki diri sehingga bisa lebih efisien selama menjalani sesi olahraga berikutnya," kata Snyderman.
Dan jika Anda berolahraga dengan bentuk yang tidak tepat hingga kelelahan, Anda benar-benar akan membakar kalori lebih sedikit daripada jika Anda berolahraga dengan benar.
Untuk mencegah kontraproduktif ini, jadwalkan setidaknya satu hari dalam sepekan libur olahraga dan variasikan sesi olahraga. Kemudian, pastikan punggung lurus dan tidak bersandar pada pegangan peralatan cardio untuk mencegah cedera dan memaksimalkan pembakaran kalori.
Buah-buahan dan sayuran segar lebih bergizi daripada dalam bentuk beku atau kalengan
Produk beku dan kalengan bisa sama-sama sehat dan bahkan lebih ekonomis daripada produk segar, tukas Snyderman. Kondisi beku pada buah-buahan seperti anggur membantu mempertahankan nutrisi.
Beberapa produk kalengan sebenarnya lebih bernutrisi daripada produk segar dan mentah. Sebab, antioksidan seperti lycopene yang ditemukan dalam tomat dan betakaroten dalam wortel lebih mudah diserap ketika telah diolah.
"Tidak masalah bagaimana Anda mendapatkan buah-buahan dan sayuran itu. Yang penting, Anda masih mengonsuminya," tegas Snyderman.
Tambah berat badan tidak dapat dihindari saat usia bertambah
"Mitos ini berasal dari kenyataan bahwa lemak perut mulai bertambah pada usia semakin tua, tetapi lemak membuncit dapat dihindari," kata Snyderman.
Sebagian besar lemak tersebut tidak bertambah, lebih karena akibat berat yang bergeser oleh kondisi perubahan hormon, setelah melahirkan, atau melemahnya tulang. Anda dapat memperlambat perubahannya dengan latihan kekuatan.
Menurut penelitian dari National Institute of Helth, kegemukan dan wanita gemuk yang mengangkat beban hanya dua kali sepekan, lemak perutnya bisa lebih kencang (7 persen wanita dengan latihan selama dua tahun) dibandingkan yang tidak berolahraga (lemak perutnya naik 21 persen dalam dua tahun).
"Kebanyakan kita mengikuti aturan-aturan tertentu untuk bagaimana menghilangkan beberapa pon bagi seluruh hidup kita," kata Nancy Snyderman MD, editor NBC News dan penulis buku Diet Myths That Keep Us Fat.
"Tetapi banyak dari apa yang telah diberitahu kepada kita tentang berat badan, sebenarnya palsu," tegasnya.
Berikut, Snyderman membuka kebenaran untuk menyangkal mitos-mitos yang berkembang seputar diet hingga tubuh langsing mungkin Anda dapatkan, seperti dibeberkan Redbook.
Semakin Anda olahraga, semakin baik
Anda tahu bahwa olahraga merupakan salah satu hal terbaik untuk menjaga berat badan dan meningkatkan kesehatan secara keseluruhan, tapi olahraga berlebihan sebenarnya memiliki efek berlawanan.
"Bekerja tujuh hari sepekan dapat melemahkan sistem kekebalan tubuh, menegangkan sendi, dan melelahkan tubuh. Otot Anda perlu waktu untuk memperbaiki diri sehingga bisa lebih efisien selama menjalani sesi olahraga berikutnya," kata Snyderman.
Dan jika Anda berolahraga dengan bentuk yang tidak tepat hingga kelelahan, Anda benar-benar akan membakar kalori lebih sedikit daripada jika Anda berolahraga dengan benar.
Untuk mencegah kontraproduktif ini, jadwalkan setidaknya satu hari dalam sepekan libur olahraga dan variasikan sesi olahraga. Kemudian, pastikan punggung lurus dan tidak bersandar pada pegangan peralatan cardio untuk mencegah cedera dan memaksimalkan pembakaran kalori.
Buah-buahan dan sayuran segar lebih bergizi daripada dalam bentuk beku atau kalengan
Produk beku dan kalengan bisa sama-sama sehat dan bahkan lebih ekonomis daripada produk segar, tukas Snyderman. Kondisi beku pada buah-buahan seperti anggur membantu mempertahankan nutrisi.
Beberapa produk kalengan sebenarnya lebih bernutrisi daripada produk segar dan mentah. Sebab, antioksidan seperti lycopene yang ditemukan dalam tomat dan betakaroten dalam wortel lebih mudah diserap ketika telah diolah.
"Tidak masalah bagaimana Anda mendapatkan buah-buahan dan sayuran itu. Yang penting, Anda masih mengonsuminya," tegas Snyderman.
Tambah berat badan tidak dapat dihindari saat usia bertambah
"Mitos ini berasal dari kenyataan bahwa lemak perut mulai bertambah pada usia semakin tua, tetapi lemak membuncit dapat dihindari," kata Snyderman.
Sebagian besar lemak tersebut tidak bertambah, lebih karena akibat berat yang bergeser oleh kondisi perubahan hormon, setelah melahirkan, atau melemahnya tulang. Anda dapat memperlambat perubahannya dengan latihan kekuatan.
Menurut penelitian dari National Institute of Helth, kegemukan dan wanita gemuk yang mengangkat beban hanya dua kali sepekan, lemak perutnya bisa lebih kencang (7 persen wanita dengan latihan selama dua tahun) dibandingkan yang tidak berolahraga (lemak perutnya naik 21 persen dalam dua tahun).
Lebih Bijak Gunakan Antibiotik, Hindari Efek Samping Fatal
Meski sering masuk ke dalam resep, mulai sekarang gunakan antibiotik dengan lebih bijak.
Antibiotik menyembuhkan penyakit dengan membunuh atau melemahkan bakteri. Penisilin adalah antibiotik pertama yang ditemukan di dunia (itu pun secara tak sengaja), dan hingga hari ini lebih dari 100 antibiotik tersedia untuk menyembuhkan penyakit ringan hingga yang membahayakan kelangsungan hidup.
Meskipun antibiotik berguna untuk menyembuhkan infeksi bakteri, tetapi jangan lupakan efek sampingnya.
Antibiotik merupakan senyawa atau kelompok obat yang dapat mencegah perkembangbiakan berbagai bakteri dan mikroorganismeberbahaya dalam tubuh. Selain itu, antibiotik juga digunakan untuk menyembuhkan penyakit menular yang disebabkan oleh protozoa dan jamur.
Tapi belum banyak orang yang tahu bahwa antibiotik juga dapat menyebabkan efek samping yang cukup membahayakan. Diberitakan dari Ehow, berikut beberapa efek samping antibiotik:
1. Gangguan pencernaan
Salah satu efek samping antibiotik yang paling umum adalah masalah pencernaan, seperti diare, mual, kram, kembung dan nyeri.
2. Gangguan fungsi jantung dan tubuh lainnya
Beberapa orang yang mengonsumsi antibiotik mengalami jantung berdebar-debar, detak jantung abnormal, sakit kepala parah, masalah hati seperti penyakit kuning, masalah ginjal seperti air kecing berwarna gelap dan batu ginjal dan masalah saraf seperti kesemutan di tangan dan kaki.
3. Infeksi
Efek samping yang paling rentan dirasakan perempuan adalah infeksi jamur pada organ reproduksi yang dapat menyebabkan keputihan, gatal dan vagina mengeluarkan bau serta cairan.
4. Alergi
Orang yang mengonsumsi antibiotik juga sering mengalami alergi, bahkan hingga bertahun-tahun. Alergi yang sering terjadi adalah gatal-gatal dan pembengkakan di mulut atau tenggorokan.
5. Resistensi (kebal)
Orang yang keseringan minum antibiotik bisa mengalami resistensi atau tidak mempan lagi dengan antibiotik. Ketika seseorang resisten terhadap antibiotik, ada beberapa penyakit dan infeksi yang tidak dapat lagi diobati, sehingga memerlukan antibiotik dengan dosis lebih tinggi. Semakin tinggi dosis maka akan semakin menimbulkan efek samping yang serius dan mengancam jiwa.
6. Gangguan serius dan mengancam nyawa
Penggunaan antibiotik dosis tinggi dan dalam jangka lama dapat menimbulkan efek sampaing yang sangat serius, seperti disfungsi atau kerusakan hati, tremor (gerakan tubuh yang tidak terkontrol), penurunan sel darah putih, kerusakan otak, kerusakan ginjal, tendon pecah, koma, aritmia jantung (gangguan irama jantung) dan bahkan kematian.
Untuk menghindari efek samping antibiotik yang berbahaya tersebut, maka sangat dianjurkan untuk menggunakan antibiotik sesuai dengan dosis dan aturan pemakaian.
Di bawah ini ada beberapa cara yang bisa membantu Anda untuk memerangi penggunaan antibiotik secara berlebihan.
Diagnosa Dengan Cermat
Jangan meminta antibiotik bila tidak perlu. Bila anak sakit, mintalah pemeriksaan (diagnosa) yang jelas. Sebab ada beberapa penyakit yang sebenarnya tidak memerlukan antibiotik.
Jika dokter mendiagnosa anak terkena flu, infeksi fungsi saluran pernapasan, atau bronchitis, biasanya anak tidak akan diberikan antibiotik. Begitu juga halnya jika anak terkena radang tenggorokan atau terkena bakteri lainnya.
Apabila dokter memberikan antibiotik setiap kali anak terkena radang tenggorokan dan tidak melakukan tes bakteri, itu tandanya anak meminum antibiotik untuk sesuatu yang tidak perlu.
Beda Virus Dan Bakteri
Pelajari perbedaan antara virus dan bakteri. Jangan langsung menggunakan antibiotik ketika anak terinfeksi virus lain seperti cacar air atau gastroenteritis (diare).
Jadi, mengapa Anda harus memberi antibiotik saat anak hanya terserang demam atau flu? Ingus yang berwarna kuning atau hijau bukan berarti infeksi sinus yang disebabkan oleh virus. Sehingga solusinya adalah harus diberikan antibiotik, kecuali memang gejala tadi sudah berlangsung dan sudah ada selama 10-14 hari atau lebih.
Tegaskan Kembali
Katakan kepada dokter, Anda tidak mengharapkan pemberian antibiotik, apalagi jika memang tidak dibutuhkan. Pasalnya, masih banyak yang mempercayai mitos, "orangtua hanya menginginkan antibiotik ketika mereka pergi ke dokter."
Padahal sering kali orangtua mengunjungi dokter hanya untuk memeriksakan apakah telinga anaknya terinfeksi atau terkena penyakit lainnya yang lebih serius. Mereka kerap kali menghibur diri dengan berpikir, ini hanya flu biasa.
Atau pada awal kunjungan, katakan kepada dokter, “Saya rasa anak saya hanya terkena flu dan akan sembuh sendiri. Saya hanya ingin memastikan jika telinganya baik-baik saja”.
Tidak ada salahnya pergi ke dokter jika anak sakit dan Anda tak harus menunggu 7-10 hari agar gejala itu hilang. Tapi yakinkan, Anda benar-benar tidak memerlukan antibiotik kecuali memang jika benar-benar dibutuhkan. Tanyakan apa yang dapat dilakukan untuk membuat anak merasa lebih baik. Itu sebenarnya tujuan Anda, kan!
Disiplin Memakainya
Pencegahan melawan penyakit-penyakit tadi sebenarnya cukup dengan menggunakan obat yang diresepkan, kompres, dan memberi banyak cairan. Itu semua dapat membantu anak merasa lebih baik sampai infeksinya sembuh.
Jika harus menggunakan antibiotik, gunakanlah sesuai resep yang diberikan. Jangan berhenti meminumnya saat sudah merasa baikan atau menyimpannya untuk digunakan lagi di kemudian hari.
Mintalah petunjuk dokter untuk mempelajari penyakit anak dan cara mengatasinya. Semata-mata agar Anda sebagai orangtua lebih paham tentang kapan sebetulnya antibiotik dibutuhkan, masalah daya tahan tubuh, dan lain-lain.
Hasilnya? Anda dan anak akan aman dari risiko pemakaian obat antibiotik secara berlebihan di kemudian hari. Jika dokter tak sempat mengajarkan Anda tentang pemakaian antibiotik, masih ada banyak sumber-sumber yang bisa digali, misalnya mencari di internet atau bertanya kepada seorang kenalan yang kompeten mengenai masalah itu. (fn/dt/t2n)
Antibiotik menyembuhkan penyakit dengan membunuh atau melemahkan bakteri. Penisilin adalah antibiotik pertama yang ditemukan di dunia (itu pun secara tak sengaja), dan hingga hari ini lebih dari 100 antibiotik tersedia untuk menyembuhkan penyakit ringan hingga yang membahayakan kelangsungan hidup.
Meskipun antibiotik berguna untuk menyembuhkan infeksi bakteri, tetapi jangan lupakan efek sampingnya.
Antibiotik merupakan senyawa atau kelompok obat yang dapat mencegah perkembangbiakan berbagai bakteri dan mikroorganismeberbahaya dalam tubuh. Selain itu, antibiotik juga digunakan untuk menyembuhkan penyakit menular yang disebabkan oleh protozoa dan jamur.
Tapi belum banyak orang yang tahu bahwa antibiotik juga dapat menyebabkan efek samping yang cukup membahayakan. Diberitakan dari Ehow, berikut beberapa efek samping antibiotik:
1. Gangguan pencernaan
Salah satu efek samping antibiotik yang paling umum adalah masalah pencernaan, seperti diare, mual, kram, kembung dan nyeri.
2. Gangguan fungsi jantung dan tubuh lainnya
Beberapa orang yang mengonsumsi antibiotik mengalami jantung berdebar-debar, detak jantung abnormal, sakit kepala parah, masalah hati seperti penyakit kuning, masalah ginjal seperti air kecing berwarna gelap dan batu ginjal dan masalah saraf seperti kesemutan di tangan dan kaki.
3. Infeksi
Efek samping yang paling rentan dirasakan perempuan adalah infeksi jamur pada organ reproduksi yang dapat menyebabkan keputihan, gatal dan vagina mengeluarkan bau serta cairan.
4. Alergi
Orang yang mengonsumsi antibiotik juga sering mengalami alergi, bahkan hingga bertahun-tahun. Alergi yang sering terjadi adalah gatal-gatal dan pembengkakan di mulut atau tenggorokan.
5. Resistensi (kebal)
Orang yang keseringan minum antibiotik bisa mengalami resistensi atau tidak mempan lagi dengan antibiotik. Ketika seseorang resisten terhadap antibiotik, ada beberapa penyakit dan infeksi yang tidak dapat lagi diobati, sehingga memerlukan antibiotik dengan dosis lebih tinggi. Semakin tinggi dosis maka akan semakin menimbulkan efek samping yang serius dan mengancam jiwa.
6. Gangguan serius dan mengancam nyawa
Penggunaan antibiotik dosis tinggi dan dalam jangka lama dapat menimbulkan efek sampaing yang sangat serius, seperti disfungsi atau kerusakan hati, tremor (gerakan tubuh yang tidak terkontrol), penurunan sel darah putih, kerusakan otak, kerusakan ginjal, tendon pecah, koma, aritmia jantung (gangguan irama jantung) dan bahkan kematian.
Untuk menghindari efek samping antibiotik yang berbahaya tersebut, maka sangat dianjurkan untuk menggunakan antibiotik sesuai dengan dosis dan aturan pemakaian.
Di bawah ini ada beberapa cara yang bisa membantu Anda untuk memerangi penggunaan antibiotik secara berlebihan.
Diagnosa Dengan Cermat
Jangan meminta antibiotik bila tidak perlu. Bila anak sakit, mintalah pemeriksaan (diagnosa) yang jelas. Sebab ada beberapa penyakit yang sebenarnya tidak memerlukan antibiotik.
Jika dokter mendiagnosa anak terkena flu, infeksi fungsi saluran pernapasan, atau bronchitis, biasanya anak tidak akan diberikan antibiotik. Begitu juga halnya jika anak terkena radang tenggorokan atau terkena bakteri lainnya.
Apabila dokter memberikan antibiotik setiap kali anak terkena radang tenggorokan dan tidak melakukan tes bakteri, itu tandanya anak meminum antibiotik untuk sesuatu yang tidak perlu.
Beda Virus Dan Bakteri
Pelajari perbedaan antara virus dan bakteri. Jangan langsung menggunakan antibiotik ketika anak terinfeksi virus lain seperti cacar air atau gastroenteritis (diare).
Jadi, mengapa Anda harus memberi antibiotik saat anak hanya terserang demam atau flu? Ingus yang berwarna kuning atau hijau bukan berarti infeksi sinus yang disebabkan oleh virus. Sehingga solusinya adalah harus diberikan antibiotik, kecuali memang gejala tadi sudah berlangsung dan sudah ada selama 10-14 hari atau lebih.
Tegaskan Kembali
Katakan kepada dokter, Anda tidak mengharapkan pemberian antibiotik, apalagi jika memang tidak dibutuhkan. Pasalnya, masih banyak yang mempercayai mitos, "orangtua hanya menginginkan antibiotik ketika mereka pergi ke dokter."
Padahal sering kali orangtua mengunjungi dokter hanya untuk memeriksakan apakah telinga anaknya terinfeksi atau terkena penyakit lainnya yang lebih serius. Mereka kerap kali menghibur diri dengan berpikir, ini hanya flu biasa.
Atau pada awal kunjungan, katakan kepada dokter, “Saya rasa anak saya hanya terkena flu dan akan sembuh sendiri. Saya hanya ingin memastikan jika telinganya baik-baik saja”.
Tidak ada salahnya pergi ke dokter jika anak sakit dan Anda tak harus menunggu 7-10 hari agar gejala itu hilang. Tapi yakinkan, Anda benar-benar tidak memerlukan antibiotik kecuali memang jika benar-benar dibutuhkan. Tanyakan apa yang dapat dilakukan untuk membuat anak merasa lebih baik. Itu sebenarnya tujuan Anda, kan!
Disiplin Memakainya
Pencegahan melawan penyakit-penyakit tadi sebenarnya cukup dengan menggunakan obat yang diresepkan, kompres, dan memberi banyak cairan. Itu semua dapat membantu anak merasa lebih baik sampai infeksinya sembuh.
Jika harus menggunakan antibiotik, gunakanlah sesuai resep yang diberikan. Jangan berhenti meminumnya saat sudah merasa baikan atau menyimpannya untuk digunakan lagi di kemudian hari.
Mintalah petunjuk dokter untuk mempelajari penyakit anak dan cara mengatasinya. Semata-mata agar Anda sebagai orangtua lebih paham tentang kapan sebetulnya antibiotik dibutuhkan, masalah daya tahan tubuh, dan lain-lain.
Hasilnya? Anda dan anak akan aman dari risiko pemakaian obat antibiotik secara berlebihan di kemudian hari. Jika dokter tak sempat mengajarkan Anda tentang pemakaian antibiotik, masih ada banyak sumber-sumber yang bisa digali, misalnya mencari di internet atau bertanya kepada seorang kenalan yang kompeten mengenai masalah itu. (fn/dt/t2n)
Jumat, 08 Oktober 2010
Tips Meminimalkan Efek Samping Pengobatan Herbal
Biasanya tanaman obat terbagi ke dalam dua macam. Pertama, herbal yang sudah dikeringkan, atau disebut simplisia. Kedua, tanaman yang masih segar, atau langsung dipetik dari pohonnya, sehingga kadar air yang dikandungnya masih banyak. Penggunaannya bisa sebagai obat dalam (diminum/ oral) atau obat luar/ topikal (dioleskan, digosok, maupun untuk obat pijat).
Pada prinsipnya, pengobatan herbal dapat memiliki potensi efek samping yang sama dengan obat-obatan sintetis. Pengobatan herbal, yang menggunakan bagian-bagian tanaman (akar, daun, batang, dll), mengandung zat-zat aktif yang bisa saja berpotensi merugikan tubuh. Tubuh kita tidak dapat membedakan apakah zat-zat aktif itu berasal dari obat pabrik atau dari ekstrak tanaman herbal .
Beberapa tanaman herbal dapat mengakibatkan masalah serius pada orang-orang dengan kondisi tertentu, misalnya orang yang menjalani operasi pembedahan, anak-anak, ibu hamil, dan orang lanjut usia. Beberapa tanaman herbal juga berpengaruh terhadap organ-organ tertentu pada semua orang.
Diperlukan kehati-hatian dalam menggunakan tanaman untuk pengobatan. Untuk meminimalkan efek samping pengobatan herbal, langkah-langkah berikut dapat dilakukan ketika kita akan menggunakan tanaman untuk pengobatan:
Tanaman yang mirip
Hati-hati mengidentifikasi jenis tanaman karena banyak tanaman yang mirip. Biasanya, tanaman yang termasuk dalam satu famili ada yang memiliki kemiripan dalam ciri-ciri fisiknya.
Kenali nama dengan teliti
Nama tanaman yang baku adalah nama ilmiah (nama latin, nama botani), nama daerah dan perdagangan seringkali rancu dan tumpang tindih.
Waktu pengumpulan/ panen
Waktu, cara pemanenan dan penanganan bahan setelah panen merupakan periode kritis yang sangat menentukan kualitas dan kuantitas hasil tanaman. Oleh karena itu waktu, cara panen dan penanganan tanaman yang tepat dan benar merupakan faktor penentu kualitas dan kuantitas. Setiap jenis tanaman memiliki waktu dan cara panen yang berbeda. Tanaman yang dipanen buahnya memiliki waktu dan cara panen yang berbeda dengan tanaman yang dipanen berupa biji, rimpang, daun, kulit dan batang. Begitu juga tanaman yang mengalami stres lingkungan akan memiliki waktu panen yang berbeda meskipun jenis tanamannya sama.
Pencucian dan pengeringan
Bahan obat yang sudah dikumpulkan segera dicuci bersih, sebaiknya dengan air yang mengalir. Setelah bersih, dapat segera dimanfaatkan bila diperlukan pemakaian bahan segar. Namun, bisa pula dikeringkan untuk disimpan dan digunakan bila sewaktu-waktu dibutuhkan.
Pengeringan bertujuan untuk mengurangi kadar air dan mengcegah pembusukan oleh cendawan atau bakteri. Dengan demikian, bahan dapat disimpan lebih lama dalam stoples atau wadah yang tertutup rapat. Bahan kering juga mudah dihaluskan bila ingin dibuat serbuk.
Berikut ini cara mengeringkan bahan obat:
Sifat dan rasa tanaman
Penggunaan tanaman obat ini harus memperhatikan sifat dan rasa tanaman. Sifat dan rasa tanaman ini berpengaruh terhadap khasiat dan efek samping pengobatan yang dihasilkan.
Di dalam Traditional Chinese Pharmacology dikenal 4 macam sifat dan 5 macam cita rasa tumbuhan obat, yang merupakan bagian dari cara pengobatan tradisional timur. Adapun keempat macam sifat tumbuhan obat itu ialah dingin, panas, hangat, dan sejuk. Tumbuhan obat yang sifatnya panas dan hangat dipakai untuk pengobatan sindroma dingin, seperti pasien yang takut dingin, tangan dan kaki dingin, lidah pucat atau nadi lambat. Tumbuhan obat yang bersifat dingin dan sejuk digunakan untuk pengobatan sindroma panas, seperti demam, rasa haus, warna kencing kuning tua, lidah merah atau denyut nadi cepat.
Lima macam cita rasa dari tumbuhan obat ialah pedas, manis, asam, pahit, dan asin. Cita rasa ini digunakan untuk tujuan tertentu karena selain berhubungan dengan organ tubuh, juga mempunyai khasiat dan kegunaan tersendiri. Misalnya rasa pedas mempunyai sifat menyebar dan merangsang. Rasa manis berkhasiat tonik dan menyejukan. Rasa asam berkhasiat mengawetkan dan pengelat. Rasa pahit dapat menghilangkan panas dan lembab. Sementara rasa asin melunakkan dan sebagai pencahar. Kadang-kadang ada juga yang menambahkan cita rasa yang keenam, yaitu netral atau tawar yang berkhasiat sebagai peluruh kencing.
Perebusan tanaman obat
Proses merebus ini bertujuan untuk mengekstrak atau menarik zat-zat aktif dari dalam tanaman obat dengan media air. Sebab, air dikenal sebagai zat pelarut yang baik. Lamanya merebus tanaman herbal tergantung dari tekstur masing-masing tanaman obat. Jika seratnya halus, seperti bunga melati, daun pegagan, dan daun kumis kucing, cukup direbus sekitar 15 menit saja. Untuk tanaman berbahan keras, misalnya kayumanis, cengkih, atau batang brotowali, perebusan akan memakan waktu lebih lama.
Perebusan umumnya dilakukan dalam pot tanah, pot keramik, atau panic email,. Pot keramik dapat dibeli di toko obat tradisional Tionghoa. Panic dari besi, alumunium atau kuningan sebaiknya tidak digunakan untuk merebus. Hal ini diingatkan karena bahan tersebut dapat menimbulkan endapan, konsentrasi larutan obat yang rendah, terbentuknya racun atau menimbulkan efek samping akibat terjadinya reaksi kimia dengan bahan obat.
Gunakan air yang bersih untuk merebus. Sebaiknya digunakan air tawar, kecuali ditentukan lain. Cara merebus bahan sebagai berikut. Bahan dimasukkan ke dalam pot tanah. Masukkan air sampai bahan terendam seluruhnya dan permukaan air sekitar 30 mm di atasnya. Perebusan dimulai bila air telah meresap ke dalam bahan ramuan obat.
Lakukan perebusan dengan api sesuai petunjuk pembuatan. Apabila nyala api tidak ditentukan, biasanya perebusan dilakukan dengan api besar sampai airnya mendidih. Selanjutnya api dikecilkan untuk mencegah air rebusan meluap atau terlalu cepat kering. Meski demikian, adakalanya api besar dan api kecil digunakan sendiri-sendiri sewaktu merebus bahan obat. Sebagai contoh, obat yang berkhasiat tonik umumnya direbus dengan api kecil sehingga zat berkhasiatnya dapat secara lengkap dikeluarkan dalam air rebusan. Demikian pula tumbuhan obat yang mengandung racun perlu direbus dengan api yang kecil dalam waktu yang agak lama, sekitar 3-5 jam untuk mengurangi kadar racunnya. Nyala api yang besar digunakan untuk ramuan obat yang dimaksudkan agar pendidihan menjadi cepat dan penguapan berlebih dari zat yang merupakan komponen aktif tumbuhan dapat dicegah.
Waktu minum obat
Bila tidak terdapat petunjuk pemakaian, biasanya obat diminum sebelum makan kecuali obat tersebut merangsang lambung maka diminum setelah makan. Obat berkhasiat tonik diminum sewaktu perut kosong, dan obat berkhasiat sedative diminum sewaktu ingin tidur. Pada penyakit kronis diminum sesuai jadwal secara teratur. Rebusan obat bisa diminum sesering mungkin sesuai kebutuhan atau diminum sebagai pengganti teh.
Cara minum obat
Obat biasanya diminum satu dosis sehari yang dibagi untuk 2-3 kali minum. Umumnya diminum selagi hangat, terutama untuk pengobatan sindroma luar. Setelah minum obat, pakailah baju tebal atau tidur berselimut supaya tubuh tetap hangat dan mudah mengeluarkan keringat.
Untuk pengobatan sindroma panas, obat diminum dalam keadaan dingin. Sebaliknya untuk pengobatan sindroma dingin obat diminum dalam keadaan hangat. Obat yang sedikit toksik, diminum sedikit demi sedikit tetapi sering. Tambahkan dosisnya secara bertahap sehingga efek pengobatan tercapai.
Lama pengobatan
Tumbuhan obat yang masih berupa simplisia, hasil pengobatannya tampak lambat, namun sifatnya konstruktif atau membangun. Hal ini berbeda dengan obat kimiawi yang hasil pengobatannya terlihat cepat namun destruktif. Oleh karena itu, obat yang berasal dari tumbuhan tidak dianjurkan penggunaannya untuk penyakit-penyakit infeksi akut. Tumbuhan obat lebih diutamakan untuk memelihara kesehatan dan pengobatan penyakit kronis yang tidak dapat disembuhkan dengan obat kimiawi, atau memerlukan kombinasi antara obat kimiawi dengan obat dari tumbuhan berkhasiat.
Tak ada ruginya memanfaatkan tanaman herbal dalam keseharian. Mulai dari meningkatkan seksualitas, menurunkan kadar kolestrol hingga melangsingkan, herbal bisa dibilang biangnya!
Menurut jurnal kesehatan, herbal Indonesia termasuk nomor dua terbaik di dunia setelah Brasil. Tak heran jika saat ini, ilmuwan asing mulai meneliti dan membukukan khasiat herbal Indonesia.
Ya, tanaman herbal memang sangat bisa dijadikan bahan terapi promotif, preventif bahkan kuratif pada gangguan-gangguan kesehatan. Bisa juga dimanfaatkan sebagai terapi masalah seksualitas hingga pelangsing, sebagaimana dipaparkan dr. Adji Suranto , anggota PDPKT DKI (Perhimpunan Dokter Indonesia Pengembang Kesehatan Tradisional Timur Wilayah DKI) dan dr. Nizmawardini, M.Kes, pengajar akupunktur (wakil ketua PDPKT DKI) juga herbalis Indonesia (peneliti PDHMI).
Pasak Bumi
Akar pasak bumi atau Eurycoma longifolia , memiliki kandungan saponin, alkaloid, tannin juga brusin dan strichnin menambah vitalitas pria serta meningkatkan produksi testosteron. Bekerja dengan mengingkatkan sirkulasi darah terutama pada alat kelamin pria, mirip viagra namun relatif lebih aman karena alami. Selain afrodisiak, akar pasak bumi juga berkhasiat mengobati malaria dan antikanker payudara.
Jahe Merah
Tanaman herbal ini memiliki manfaat analgetik dan anastesi lebih kuat dibanding jahe putih. Sebagai peningkat gairah seksual, jahe merah bekerja membuat emosi lebih tenang sehingga mood dan gairah seksual menjadi lebih baik, bermanfaat sebagai stimulan gairah seksual pria dan wanita.
Kunyit
Ia bekerja sebagai astringent yang menyejukkan tubuh dan membuat emosi menjadi lebih baik, mengurangi kelelahan akibat aktivitas tinggi sehingga lebih tenang.
Bersama adas dan jahe merah, kunyit ampuh membangkitkan gairah seks untuk pria dan wanita. Sementara kandungan tanin dan minyak asirinya juga berkhasiat menurunkan kolesterol.
Khasiat lainnya, sebagai anti koagulan sehingga baik dikonsumsi orang dengan gangguan kardiovaskular.
Adas
Foeniculum vulgare Mill. , adalah afrodisiak alami. Baunya khas dan mampu menghangatkan tubuh serta meningkatkan efektivitas prostaglandin sehingga meningkatkan gairah seksual.
Pada ibu menyusui, adas juga bermanfaat memperlancar produksi ASI serta menghentikan menstruasi.
Lengkuas Merah
Tanaman yang memiliki khasiat analgetik dan stimulan ini bekerja layaknya afrodisiak karena berkhasiat memperbaiki metabolisme dan meningkatkan gairah seksual.
Pada wanita, lengkuas merah juga bermanfaat mencegah keputihan karena mampu mematikan jamur Candida albicans .
Mengkudu
Si Noni ini dapat memperbaiki prostaglandin serta memperlancar buang air besar. Tak salah jika mengkudu dinobatkan menjadi obat pelangsing tradisional, kan? Selain itu, ekstrak buah segarnya dapat memperbaiki sirkulasi darah, menurunkan demam, hipertensi serta gula darah.
Aloe Vera
Lidah buaya (nama populernya) sangat dikenal sebagai penyubur rambut. Namun, tahukah Anda, aloe vera juga dapat membantu meluruhkan haid?
Dan, di balik itu semua, lidah buaya juga bermanfaat sebagai pelangsing dengan efek laksatif yang dimilikinya sehingga membantu memperlancar BAB.
Teh Hijau
Kandungan asam tanatnya menghalangi absorbsi lemak di lambung dan bersifat laksatif sehingga memperlancar BAB. Kadar kalium yang tinggi dimilikinya pun memberikan efek diuretik (sering BAK) sehingga dikatakan sebagai pelangsing yang cukup efektif.
Jangan lupa, kandungan EGCG di dalamnya berguna sebagai anti oksidan yang baik untuk kesehatan. Mengonsumsi 5 cangkir teh hijau, dapat melancarkan metabolisme dan membakar sekitar 80 kal energi.
Jati Belanda
Mirip dengan teh hijau, kandungan asam tanat yang dimilikinya mampu menghambat absorbsi lemak. Ia pun mampu menurunkan aktivitas enzim lipase sehingga lemak tidak mudah terangkut ke dalam darah.
Efek astringen-nya mengerutkan lapisan dalam usus sehingga menurunkan penyerapan lemak. Namun ada efek lain dari konsumsi teh jati belanda yang dapat menekan peristaltik usus, sehingga sebagai pelangsing ia perlu dikombinasi dengan herbal lain.
Temulawak
Selain terkenal sebagai tanamah obat hepatoprotektor yang berkhasiat meningkatkan efektivitas kerja hati, temulawak juga mampu memperlancar emulsi lemak sehingga dikatakan sebagai herbal pelangsing. Kombinasikan ekstrak temulawak dengan asam jawa untuk rasa dan meningkatkan kemampuan mengganggu penyerapan lemak.
Sayangnya, kandungan minyak asiri yang dimilikinya berefek mempercepat pengosongan lambung sehingga dapat mempercepat rasa lapar.
Kemuning
Daun kemuning dikatakan memiliki kandungan asam tanat yang dapat menghalangi absorbsi lemak di lambung. Selain sebagai pelangsing, kemuning juga berkhasiat menghaluskan kulit dan memperlancar datang bulan.
Kunci Pepet
Kunci pepet (kunyit putih atau Kaemferia rotunda L. ), adalah herbal pelangsing.
Rimpang kunci pepet yang mengandung minyak asiri, borneol, sineol, metil khavikol dan saponin juga bisa dimanfaatkan untuk meluruhkan gas perut sekaligus mengatasi sakit perut.
Bawang Putih
Konsumsi 2 siung bawang putih segar pagi dan sore dikatakan mampu menurunkan risiko hiperkolestrolemia. Khasiat anti kanker dan anti trombolitik (mengurangi plak di pembuluh darah) yang bermafaat menurunkan risiko penyakit kardiovaskular.
Salam
Daun salam dikatakan mampu menurunkan kolesterol dan juga gula darah sekaligus. Mengonsumsi rebusan 5 lembar daun salam per takaran saji dapat menjaga kolesterol dan gula darah tetap stabil. Sedangkan untuk pengobatan bisa ditingkatkan hingga 7 lembar daun salam.
Khusus untuk pasien diabetes, konsumsi rebusan daun salam sebaiknya diminum setelah makan.
Bengle
Menurut penelitian, bengle mampu meningkatkan aktivitas enzim lipase yg berfungsi menghidrosis lemak tubuh. Selain itu, meningkatkan aktivitas enzim lipase yang berfungsi mengurai lemak menjadi asam lemak dan gliserol. Menghambat enzim lipase pankreatik dalam penyerapan lemak sehingga lemak dibuang bersama feses. Menghambat biosintesis kolesterol, menurunkan LDL dan meningkatkan HDL.
Aturan Pakai Si Herbal
Mengonsumsi herbal juga ada aturan pakainya, agar bahan herbal bisa bekerja maksimal. Perhatikan beberapa tips berikut!
1. Jangan konsumsi herbal bersama dengan obat konvensional (jika masih mengonsumsi obat dokter, konsumsi lebih dari 1-2 jam).
2. Sesuaikan konsumsi herbal dengan jam piket tubuh, misal herbal yg bersifat laksatif sebaiknya dikonsumsi sebelum tidur, agar usus besar bekerja maksimal pada pukul 5-7 pagi. Herbal lainnya, dapat diminum pukul 9 pagi dan 3 sore (saat lambung kosong).
3. Konsumsi herbal sebaiknya dengan air hangat.
4. Herbal mengandung minyak asiri seperti pada rimpang-rimpangan, sebaiknya tidak dimasak dan tidak dikeringkan agar tidak hilang.
5. Herbal tidak menimbulkan efek segera seperti obat konvensional, umumnya terapi herbal menunjukkan hasil setelah konsumsi lebih dari 6 bulan.
6. Bila menggunakan bahan herbal kering, pastikan tidak berjamur dan bisa diidentifikasi.
7. Merebus bahan herbal sebaiknya menggunakan panci pyrex, stainless steel atau tanah.
8. Setelah merebus mendidih pertama, kecilkan api 15 menit untuk daun yang lembut atau 30 menit utk bahan yang lebih keras (kayu atau biji).
9. Pencampuran herbal dibatasi maksimum 5 bahan dalam satu ramuan.
10. Ekstraksi melalui rebusan daun segar 30-40 gr, 10-15 gr daun kering atau satu jari rimpang per takaran. Rebus dalam air 2 gelas, setelah tinggal 1 gelas, saring dan dikonsumsi. (fn/sc/tn)
Pada prinsipnya, pengobatan herbal dapat memiliki potensi efek samping yang sama dengan obat-obatan sintetis. Pengobatan herbal, yang menggunakan bagian-bagian tanaman (akar, daun, batang, dll), mengandung zat-zat aktif yang bisa saja berpotensi merugikan tubuh. Tubuh kita tidak dapat membedakan apakah zat-zat aktif itu berasal dari obat pabrik atau dari ekstrak tanaman herbal .
Beberapa tanaman herbal dapat mengakibatkan masalah serius pada orang-orang dengan kondisi tertentu, misalnya orang yang menjalani operasi pembedahan, anak-anak, ibu hamil, dan orang lanjut usia. Beberapa tanaman herbal juga berpengaruh terhadap organ-organ tertentu pada semua orang.
Diperlukan kehati-hatian dalam menggunakan tanaman untuk pengobatan. Untuk meminimalkan efek samping pengobatan herbal, langkah-langkah berikut dapat dilakukan ketika kita akan menggunakan tanaman untuk pengobatan:
Tanaman yang mirip
Hati-hati mengidentifikasi jenis tanaman karena banyak tanaman yang mirip. Biasanya, tanaman yang termasuk dalam satu famili ada yang memiliki kemiripan dalam ciri-ciri fisiknya.
Kenali nama dengan teliti
Nama tanaman yang baku adalah nama ilmiah (nama latin, nama botani), nama daerah dan perdagangan seringkali rancu dan tumpang tindih.
Waktu pengumpulan/ panen
Waktu, cara pemanenan dan penanganan bahan setelah panen merupakan periode kritis yang sangat menentukan kualitas dan kuantitas hasil tanaman. Oleh karena itu waktu, cara panen dan penanganan tanaman yang tepat dan benar merupakan faktor penentu kualitas dan kuantitas. Setiap jenis tanaman memiliki waktu dan cara panen yang berbeda. Tanaman yang dipanen buahnya memiliki waktu dan cara panen yang berbeda dengan tanaman yang dipanen berupa biji, rimpang, daun, kulit dan batang. Begitu juga tanaman yang mengalami stres lingkungan akan memiliki waktu panen yang berbeda meskipun jenis tanamannya sama.
- Daun dipetik saat tanaman berbunga s/d buah belum masak.
- Bunga dikumpulkan sebelum atau setelah mekar.
- Buah dipetik dalam keadaan masak.
- Biji dikumpulkan dari buah masak sempurna.
- Akar, rimpang, umbi dan umbi lapis waktu tanaman tidak tumbuh lagi.
Pencucian dan pengeringan
Bahan obat yang sudah dikumpulkan segera dicuci bersih, sebaiknya dengan air yang mengalir. Setelah bersih, dapat segera dimanfaatkan bila diperlukan pemakaian bahan segar. Namun, bisa pula dikeringkan untuk disimpan dan digunakan bila sewaktu-waktu dibutuhkan.
Pengeringan bertujuan untuk mengurangi kadar air dan mengcegah pembusukan oleh cendawan atau bakteri. Dengan demikian, bahan dapat disimpan lebih lama dalam stoples atau wadah yang tertutup rapat. Bahan kering juga mudah dihaluskan bila ingin dibuat serbuk.
Berikut ini cara mengeringkan bahan obat:
- Bahan berukuran besar dan banyak mengandung air dapat dipotong-potong seperlunya terlebih dahulu.
- Pengeringan bisa langsung di bawah sinar matahari, atau memakai pelindung seperti kawat halus jika menghendaki pengeringan yang tidak terlalu cepat.
- Pengeringan bisa juga dilakukan dengan mengangin-anginkan bahan di tempat yang teduh atau di dalam ruang pengering yang aliran udaranya baik.
Sifat dan rasa tanaman
Penggunaan tanaman obat ini harus memperhatikan sifat dan rasa tanaman. Sifat dan rasa tanaman ini berpengaruh terhadap khasiat dan efek samping pengobatan yang dihasilkan.
Di dalam Traditional Chinese Pharmacology dikenal 4 macam sifat dan 5 macam cita rasa tumbuhan obat, yang merupakan bagian dari cara pengobatan tradisional timur. Adapun keempat macam sifat tumbuhan obat itu ialah dingin, panas, hangat, dan sejuk. Tumbuhan obat yang sifatnya panas dan hangat dipakai untuk pengobatan sindroma dingin, seperti pasien yang takut dingin, tangan dan kaki dingin, lidah pucat atau nadi lambat. Tumbuhan obat yang bersifat dingin dan sejuk digunakan untuk pengobatan sindroma panas, seperti demam, rasa haus, warna kencing kuning tua, lidah merah atau denyut nadi cepat.
Lima macam cita rasa dari tumbuhan obat ialah pedas, manis, asam, pahit, dan asin. Cita rasa ini digunakan untuk tujuan tertentu karena selain berhubungan dengan organ tubuh, juga mempunyai khasiat dan kegunaan tersendiri. Misalnya rasa pedas mempunyai sifat menyebar dan merangsang. Rasa manis berkhasiat tonik dan menyejukan. Rasa asam berkhasiat mengawetkan dan pengelat. Rasa pahit dapat menghilangkan panas dan lembab. Sementara rasa asin melunakkan dan sebagai pencahar. Kadang-kadang ada juga yang menambahkan cita rasa yang keenam, yaitu netral atau tawar yang berkhasiat sebagai peluruh kencing.
Perebusan tanaman obat
Proses merebus ini bertujuan untuk mengekstrak atau menarik zat-zat aktif dari dalam tanaman obat dengan media air. Sebab, air dikenal sebagai zat pelarut yang baik. Lamanya merebus tanaman herbal tergantung dari tekstur masing-masing tanaman obat. Jika seratnya halus, seperti bunga melati, daun pegagan, dan daun kumis kucing, cukup direbus sekitar 15 menit saja. Untuk tanaman berbahan keras, misalnya kayumanis, cengkih, atau batang brotowali, perebusan akan memakan waktu lebih lama.
Perebusan umumnya dilakukan dalam pot tanah, pot keramik, atau panic email,. Pot keramik dapat dibeli di toko obat tradisional Tionghoa. Panic dari besi, alumunium atau kuningan sebaiknya tidak digunakan untuk merebus. Hal ini diingatkan karena bahan tersebut dapat menimbulkan endapan, konsentrasi larutan obat yang rendah, terbentuknya racun atau menimbulkan efek samping akibat terjadinya reaksi kimia dengan bahan obat.
Gunakan air yang bersih untuk merebus. Sebaiknya digunakan air tawar, kecuali ditentukan lain. Cara merebus bahan sebagai berikut. Bahan dimasukkan ke dalam pot tanah. Masukkan air sampai bahan terendam seluruhnya dan permukaan air sekitar 30 mm di atasnya. Perebusan dimulai bila air telah meresap ke dalam bahan ramuan obat.
Lakukan perebusan dengan api sesuai petunjuk pembuatan. Apabila nyala api tidak ditentukan, biasanya perebusan dilakukan dengan api besar sampai airnya mendidih. Selanjutnya api dikecilkan untuk mencegah air rebusan meluap atau terlalu cepat kering. Meski demikian, adakalanya api besar dan api kecil digunakan sendiri-sendiri sewaktu merebus bahan obat. Sebagai contoh, obat yang berkhasiat tonik umumnya direbus dengan api kecil sehingga zat berkhasiatnya dapat secara lengkap dikeluarkan dalam air rebusan. Demikian pula tumbuhan obat yang mengandung racun perlu direbus dengan api yang kecil dalam waktu yang agak lama, sekitar 3-5 jam untuk mengurangi kadar racunnya. Nyala api yang besar digunakan untuk ramuan obat yang dimaksudkan agar pendidihan menjadi cepat dan penguapan berlebih dari zat yang merupakan komponen aktif tumbuhan dapat dicegah.
Waktu minum obat
Bila tidak terdapat petunjuk pemakaian, biasanya obat diminum sebelum makan kecuali obat tersebut merangsang lambung maka diminum setelah makan. Obat berkhasiat tonik diminum sewaktu perut kosong, dan obat berkhasiat sedative diminum sewaktu ingin tidur. Pada penyakit kronis diminum sesuai jadwal secara teratur. Rebusan obat bisa diminum sesering mungkin sesuai kebutuhan atau diminum sebagai pengganti teh.
Cara minum obat
Obat biasanya diminum satu dosis sehari yang dibagi untuk 2-3 kali minum. Umumnya diminum selagi hangat, terutama untuk pengobatan sindroma luar. Setelah minum obat, pakailah baju tebal atau tidur berselimut supaya tubuh tetap hangat dan mudah mengeluarkan keringat.
Untuk pengobatan sindroma panas, obat diminum dalam keadaan dingin. Sebaliknya untuk pengobatan sindroma dingin obat diminum dalam keadaan hangat. Obat yang sedikit toksik, diminum sedikit demi sedikit tetapi sering. Tambahkan dosisnya secara bertahap sehingga efek pengobatan tercapai.
Lama pengobatan
Tumbuhan obat yang masih berupa simplisia, hasil pengobatannya tampak lambat, namun sifatnya konstruktif atau membangun. Hal ini berbeda dengan obat kimiawi yang hasil pengobatannya terlihat cepat namun destruktif. Oleh karena itu, obat yang berasal dari tumbuhan tidak dianjurkan penggunaannya untuk penyakit-penyakit infeksi akut. Tumbuhan obat lebih diutamakan untuk memelihara kesehatan dan pengobatan penyakit kronis yang tidak dapat disembuhkan dengan obat kimiawi, atau memerlukan kombinasi antara obat kimiawi dengan obat dari tumbuhan berkhasiat.
Tak ada ruginya memanfaatkan tanaman herbal dalam keseharian. Mulai dari meningkatkan seksualitas, menurunkan kadar kolestrol hingga melangsingkan, herbal bisa dibilang biangnya!
Menurut jurnal kesehatan, herbal Indonesia termasuk nomor dua terbaik di dunia setelah Brasil. Tak heran jika saat ini, ilmuwan asing mulai meneliti dan membukukan khasiat herbal Indonesia.
Ya, tanaman herbal memang sangat bisa dijadikan bahan terapi promotif, preventif bahkan kuratif pada gangguan-gangguan kesehatan. Bisa juga dimanfaatkan sebagai terapi masalah seksualitas hingga pelangsing, sebagaimana dipaparkan dr. Adji Suranto , anggota PDPKT DKI (Perhimpunan Dokter Indonesia Pengembang Kesehatan Tradisional Timur Wilayah DKI) dan dr. Nizmawardini, M.Kes, pengajar akupunktur (wakil ketua PDPKT DKI) juga herbalis Indonesia (peneliti PDHMI).
Pasak Bumi
Akar pasak bumi atau Eurycoma longifolia , memiliki kandungan saponin, alkaloid, tannin juga brusin dan strichnin menambah vitalitas pria serta meningkatkan produksi testosteron. Bekerja dengan mengingkatkan sirkulasi darah terutama pada alat kelamin pria, mirip viagra namun relatif lebih aman karena alami. Selain afrodisiak, akar pasak bumi juga berkhasiat mengobati malaria dan antikanker payudara.
Jahe Merah
Tanaman herbal ini memiliki manfaat analgetik dan anastesi lebih kuat dibanding jahe putih. Sebagai peningkat gairah seksual, jahe merah bekerja membuat emosi lebih tenang sehingga mood dan gairah seksual menjadi lebih baik, bermanfaat sebagai stimulan gairah seksual pria dan wanita.
Kunyit
Ia bekerja sebagai astringent yang menyejukkan tubuh dan membuat emosi menjadi lebih baik, mengurangi kelelahan akibat aktivitas tinggi sehingga lebih tenang.
Bersama adas dan jahe merah, kunyit ampuh membangkitkan gairah seks untuk pria dan wanita. Sementara kandungan tanin dan minyak asirinya juga berkhasiat menurunkan kolesterol.
Khasiat lainnya, sebagai anti koagulan sehingga baik dikonsumsi orang dengan gangguan kardiovaskular.
Adas
Foeniculum vulgare Mill. , adalah afrodisiak alami. Baunya khas dan mampu menghangatkan tubuh serta meningkatkan efektivitas prostaglandin sehingga meningkatkan gairah seksual.
Pada ibu menyusui, adas juga bermanfaat memperlancar produksi ASI serta menghentikan menstruasi.
Lengkuas Merah
Tanaman yang memiliki khasiat analgetik dan stimulan ini bekerja layaknya afrodisiak karena berkhasiat memperbaiki metabolisme dan meningkatkan gairah seksual.
Pada wanita, lengkuas merah juga bermanfaat mencegah keputihan karena mampu mematikan jamur Candida albicans .
Mengkudu
Si Noni ini dapat memperbaiki prostaglandin serta memperlancar buang air besar. Tak salah jika mengkudu dinobatkan menjadi obat pelangsing tradisional, kan? Selain itu, ekstrak buah segarnya dapat memperbaiki sirkulasi darah, menurunkan demam, hipertensi serta gula darah.
Aloe Vera
Lidah buaya (nama populernya) sangat dikenal sebagai penyubur rambut. Namun, tahukah Anda, aloe vera juga dapat membantu meluruhkan haid?
Dan, di balik itu semua, lidah buaya juga bermanfaat sebagai pelangsing dengan efek laksatif yang dimilikinya sehingga membantu memperlancar BAB.
Teh Hijau
Kandungan asam tanatnya menghalangi absorbsi lemak di lambung dan bersifat laksatif sehingga memperlancar BAB. Kadar kalium yang tinggi dimilikinya pun memberikan efek diuretik (sering BAK) sehingga dikatakan sebagai pelangsing yang cukup efektif.
Jangan lupa, kandungan EGCG di dalamnya berguna sebagai anti oksidan yang baik untuk kesehatan. Mengonsumsi 5 cangkir teh hijau, dapat melancarkan metabolisme dan membakar sekitar 80 kal energi.
Jati Belanda
Mirip dengan teh hijau, kandungan asam tanat yang dimilikinya mampu menghambat absorbsi lemak. Ia pun mampu menurunkan aktivitas enzim lipase sehingga lemak tidak mudah terangkut ke dalam darah.
Efek astringen-nya mengerutkan lapisan dalam usus sehingga menurunkan penyerapan lemak. Namun ada efek lain dari konsumsi teh jati belanda yang dapat menekan peristaltik usus, sehingga sebagai pelangsing ia perlu dikombinasi dengan herbal lain.
Temulawak
Selain terkenal sebagai tanamah obat hepatoprotektor yang berkhasiat meningkatkan efektivitas kerja hati, temulawak juga mampu memperlancar emulsi lemak sehingga dikatakan sebagai herbal pelangsing. Kombinasikan ekstrak temulawak dengan asam jawa untuk rasa dan meningkatkan kemampuan mengganggu penyerapan lemak.
Sayangnya, kandungan minyak asiri yang dimilikinya berefek mempercepat pengosongan lambung sehingga dapat mempercepat rasa lapar.
Kemuning
Daun kemuning dikatakan memiliki kandungan asam tanat yang dapat menghalangi absorbsi lemak di lambung. Selain sebagai pelangsing, kemuning juga berkhasiat menghaluskan kulit dan memperlancar datang bulan.
Kunci Pepet
Kunci pepet (kunyit putih atau Kaemferia rotunda L. ), adalah herbal pelangsing.
Rimpang kunci pepet yang mengandung minyak asiri, borneol, sineol, metil khavikol dan saponin juga bisa dimanfaatkan untuk meluruhkan gas perut sekaligus mengatasi sakit perut.
Bawang Putih
Konsumsi 2 siung bawang putih segar pagi dan sore dikatakan mampu menurunkan risiko hiperkolestrolemia. Khasiat anti kanker dan anti trombolitik (mengurangi plak di pembuluh darah) yang bermafaat menurunkan risiko penyakit kardiovaskular.
Salam
Daun salam dikatakan mampu menurunkan kolesterol dan juga gula darah sekaligus. Mengonsumsi rebusan 5 lembar daun salam per takaran saji dapat menjaga kolesterol dan gula darah tetap stabil. Sedangkan untuk pengobatan bisa ditingkatkan hingga 7 lembar daun salam.
Khusus untuk pasien diabetes, konsumsi rebusan daun salam sebaiknya diminum setelah makan.
Bengle
Menurut penelitian, bengle mampu meningkatkan aktivitas enzim lipase yg berfungsi menghidrosis lemak tubuh. Selain itu, meningkatkan aktivitas enzim lipase yang berfungsi mengurai lemak menjadi asam lemak dan gliserol. Menghambat enzim lipase pankreatik dalam penyerapan lemak sehingga lemak dibuang bersama feses. Menghambat biosintesis kolesterol, menurunkan LDL dan meningkatkan HDL.
Aturan Pakai Si Herbal
Mengonsumsi herbal juga ada aturan pakainya, agar bahan herbal bisa bekerja maksimal. Perhatikan beberapa tips berikut!
1. Jangan konsumsi herbal bersama dengan obat konvensional (jika masih mengonsumsi obat dokter, konsumsi lebih dari 1-2 jam).
2. Sesuaikan konsumsi herbal dengan jam piket tubuh, misal herbal yg bersifat laksatif sebaiknya dikonsumsi sebelum tidur, agar usus besar bekerja maksimal pada pukul 5-7 pagi. Herbal lainnya, dapat diminum pukul 9 pagi dan 3 sore (saat lambung kosong).
3. Konsumsi herbal sebaiknya dengan air hangat.
4. Herbal mengandung minyak asiri seperti pada rimpang-rimpangan, sebaiknya tidak dimasak dan tidak dikeringkan agar tidak hilang.
5. Herbal tidak menimbulkan efek segera seperti obat konvensional, umumnya terapi herbal menunjukkan hasil setelah konsumsi lebih dari 6 bulan.
6. Bila menggunakan bahan herbal kering, pastikan tidak berjamur dan bisa diidentifikasi.
7. Merebus bahan herbal sebaiknya menggunakan panci pyrex, stainless steel atau tanah.
8. Setelah merebus mendidih pertama, kecilkan api 15 menit untuk daun yang lembut atau 30 menit utk bahan yang lebih keras (kayu atau biji).
9. Pencampuran herbal dibatasi maksimum 5 bahan dalam satu ramuan.
10. Ekstraksi melalui rebusan daun segar 30-40 gr, 10-15 gr daun kering atau satu jari rimpang per takaran. Rebus dalam air 2 gelas, setelah tinggal 1 gelas, saring dan dikonsumsi. (fn/sc/tn)
Ilmuwan Eropa Klaim Temukan Ramuan Asam Amino "Pemanjang Usia"
Meskipun baru tahap sukses uji coba pada tikus, para ilmuwan itu yakin bahwa ramuan tersebut akan bermanfaat bagi manusia, terutama mereka yang menderita sakit dan berusia lanjut.
Seperti dilansir Telegraph, para ilmuwan dari University Of Milan Italia menggunakan campuran tertentu asam amino yang dilarutkan ke dalam air dan kemudian diberikan pada seekor tikus berusia menengah. Umur tikus itu kemudian bertambah panjang secara signifikan daripada tikus lain yang tidak menerima asupan cairan itu.
Tikus yang diberi campuran dari tiga asam amino, yakni leusin, isoleusin, dan valin, memiliki rentang masa hidup dengan titik tengah 869 hari. Sementara tikus yang tidak mengonsumsi ramuan titik tengahnya hanya 774 hari atau memiliki perbedaan 12 persen.
Bertambah panjangnya umur juga diikuti dengan perubahan biologis yang mendorong ketersediaan energi ke dalam sel dan mengurangi kerusakan oksidatif yang disebabkan oleh molekul-molekul destruktif yang dikenal dengan nama radikal bebas. Alhasil, tikus yang diberi campuran asam amino itu memiliki stamina lebih dan koordinasi otot yang lebih baik.
"Ini adalah pembuktian pertama bahwa campuran asam amino bisa memperpanjang umur tikus," kata Dr Enzo Nisoli, pemimpin penelitian itu.
Setahun lalu, para ilmuwan telah menunjukan bahwa campuran asam amino yang sama bisa memperpanjang usia dari makhluk bersel satu.
Para peneliti itu juga menekankan, seperti yang dirilis dalam jurnal Cell Metabolism, eksperimen menggunakan tikus itu tidak saja berhubungan dengan memperpanjang usia, tetapi juga meningkatkan kesehatan.
Para ilmuwan itu percaya bahwa campuran asam amino bisa membantu orang-orang lanjut usia dan penderita sakit, khususnya yang menderita penyakit hati dan paru-paru akut serta mereka yang menderita penyakit yang ditandai oleh berkurangnya energi.
Leusin, isoleusin, dan valin merupakan bagian dari asam amino yang tampaknya mempunyai bahan anti-penuaan.
Tikus yang diberikan tiga campuran asam amino itu terbukti memproduksi lebih banyak mitokondria, bagian sel yang berfungsi menghasilkan energi, terutama di organ hati dan otot rangka.
Menurut para peneliti, mengonsumsi asam amino cenderung lebih efisien daripada mengonsumsi protein yang mengandung asam amino yang sama. Berbeda dengan protein, asam amino tidak perlu dicerna dan bisa langsung masuk ke dalam aliran darah. "Asam amino itu tidak menghabiskan energi," kata Dr Nisoli. (Kompas.com)
Cara Alami Tingkatkan Kekebalan Tubuh

Bakteri, virus, parasit, jamur yang berada di mana-mana (sekolah, rumah, kantor, dan tempat-tempat lainnya berpotensi menimbulkan munculnya penyakit. Sistem imun yang sehat akan menjaga tubuh. Bagaimana caranya?
Pola makan dan asupan nutrisi yang tak benar adalah salah satu penyebab rendahnya sistem kekebalan tubuh. Jangan abaikan kondisi ini. Sistem kekebalan tubuh yang buruk membuat tubuh mudah lelah dan rentan terserang penyakit.
Ada cara mudah untuk mempertahankan sistem kekebalan tubuh. Pilih beberapa sumber makanan yang mengandung nutrisi penting untuk tubuh.
Jamur adalah makanan yang cukup populer untuk meningkatkan sistem kekebalan tubuh. "Penelitian menunjukkan bahwa jamur meningkatkan produksi dan aktivitas sel darah putih. Ini sangat baik bila tubuh mengalami infeksi,” kata Douglas Schar, Direktur Institute of Herbal Medicine di Washington DC, AS. Salah satu jamur termahal, shiitake, adalah yang memiliki nutrisi paling baik untuk kekebalan tubuh. Jamur maitake juga memiliki manfaat yang sama. Anda bisa mengolahnya sesuai menu favorit Anda.
Selain itu, makanan mengandung zinc dan antioksidan juga cukup baik untuk meningkatkan kekebalan tubuh. Zinc membantu tubuh meningkatkan kemampuan mencegah peradangan dan in feksi. Zinc membantu tubuh memproduksi sel darah putih yang menjadi tameng dari berbagai virus, kuman, dan bakteri. Sedangkan antioksidan berperan melindungi sel tubuh dari kerusakan.
Sumber pangan yang kaya kandungan zinc antara lain daging sapi, tiram, daging unggas, susu, dan yogurt. Sementara antioksidan bisa diperoleh melalui konsumsi teh. Teh hijau dan teh hitam kaya kandungan polifenol yang merupakan antioksidan yang baik.
Beberapa hal sederhana yang dapat dilakukan untuk meningkatkan daya tahan tubuh, antara lain:
- Hindari penggunaan antibiotik yang berlebihan dan tidak rasional karena dapat mengakibatkan mudah terserang penyakit lebih lama, dan juga sulit diatasi karena kuman telah kebal.
- Tidur yang cukup. Kurang tidur dapat berakibat buruk bagi daya tahan tubuh.
- Hindari alkohol, rokok, dan narkoba.
- Hindari berdekatan dengan perokok (menjadi perokok pasif).
- Mengkonsumsi air minimal 2 liter setiap harinya.
- Mengkonsumsi makanan yang baik dan seimbang.
- Mencuci tangan hingga bersih menggunakan sabun dan air yang mengalir.
- Mendapat cukup sinar matahari dan udara segar yang bersih.
- Olahraga teratur.
- Mengendalikan emosi dan stres.
- Bekerja dan beristirahat secara seimbang. Biasakan untuk tidur malam 7 hingga 8 jam setiap harinya.
Sementara itu, beberapa faktor yang menyebabkan menurunnya kekebalan tubuh, antara lain:
- Usia, semakin muda seseorang fungsi sistem imunitasnya belum sempurna.
- Kematangan saluran cerna.
- Lingkungan yang tidak bersih.
- Infeksi
- Status gizi.
- Penyakit kronis yang diderita, seperti jantung, kanker, atau kelainan darah
Penyebab Gigi Ngilu Dan Tips Mengakalinya

Biasanya rasa ngilu yang timbul terasa sangat tajam, singkat dan seringkali tidak terdiagnosis bahkan terabaikan. Tak mengherankan jika 50 persen penduduk Indonesia mengalami masalah gigi sensitif bahkan tanpa mereka sadari.
Masalah gigi sensitif bukanlah insiden yang timbul akibat penyakit gigi, namun terjadi akibat menipisnya enamel, penurunan gusi dan terbukanya dentin (sebuah lapisan di bawah enamel). Nyeri yang berkaitan dengan sensitivitas umumnya terjadi dalam saraf gigi.
“Biasanya masalah gigi sensitif mulai dialami saat usia 20- 50 tahun. Tapi, siapa bisa menduga, penderita gigi sensitif banyak dialami wanita yang menganut hidup bersih,” kata Maria Melisa, Dental Datailing Manager, GSK Consumer Healthcare, saat Media Briefing, Sensodyne Expert Sharing di FKG UI, Jakarta. Kebanyakan wanita ingin tampil dengan gigi yang bersih dan putih. Sering melakukan bleaching gigi, bahkan menggosok gigi dengan tekanan berlebih. Melisa menambahkan, kebiasaan menggosok gigi dengan tekanan berlebih dapat membuat gusi mengalami iritasi atau gusi menurun dari leher gigi. Akkibatnya, lama kelamaan akar gigi akan terbuka (resesi gingiva), leher gigi berlubang, lapisan email pun akan berkurang ketebalannya sehingga bila minum air dingin, asam/manis atau bahkan tersentuh bulu sikat gigi pun akan terasa ngilu.
Pembentukan lapisan email gigi yang kurang sempurna (ename hypoplasia) dapat pula terjadi pada kasus tertentu. Keadaan ini pun akan menjadikan gigi menjadi sensitif.
Selain itu, penumpukan sisa-sisa makanan di daerah pertemuan gigi juga bisa menimbulkan gigi ngilu. Sisa makanan ini menyusup masuk melalui leher gigi dan sulit terjangkau sikat gigi sehingga akan sulit dibersihkan, lama kelamaan penumpukannya akan makin banyak, dan menekan saku gusi makin dalam dari keadaan normal.
Secara garis besar penyebab sensitivitas gigi, antara lain:
1. Penurunan Gusi
2. Buruknya kebersihan gigi dan mulut
3. Bleaching (pemutihan permukaan gigi)
4. Terkikisnya email
5. Penyikatan gigi terlalu kuat
6. Pasien lansia
7. Kebiasaan konsumsi makanan/minuman yang bersifat asam
8. Mulut kering dan produksi air liur sedikit
9.Sering mengalami gigi gerinding saat tidur
10. Infeksi gusi yang terus menerus
“Masalah gigi sensitif bisa diatasi, yakni dengan menggunakan pasta gigi mengandung potassium nitrat and strontium chlorida,” kata Dekan FKG Universitas Indonesia, Drg. Robert Lessang menambahkan.
Tak hanya itu, Robert juga menyarankan, agar tidak lekas menyikat gigi setelah makan. Menyikat gigi setelah makan bisa memicu terjadinya gigi sensitif karena PH di dalam mulut mengalami penurunan. Sehingga ada baiknya menunda menggosok gigi setelah makan atau melakukan sikat gigi 25 menit setelahnya. Saat menggosok gigi gunakan bulu sikat yang lembut tanpa harus menggosok dengan kuat.
“Jika masalah gigi sensitif terus menganggu, lakukan konsultasi dengan dokter agar dilakukan perawatan lebih intensif untuk mengurangi pergerakan cairan dalam tubuli dentin dan menghambat respon ujung-ujung saraf penyebab nyeri,” katanya.
Menggosok gigi setidaknya dua kali sehari sudah menjadi salah satu ritual keseharian kita.
“Upacara” itu setidaknya mampu mencegah hadirnya plak, biang keladi sejumlah masalah di mulut.
Banyak orang mengaku telah menggosok gigi setiap hari. Namun, mereka masih saja mengeluh dihantam masalah gigi. Entah giginya berlubang, gusi meradang, gigi berkarang, atau mulut bau naga. Lantas, apanya yang salah? Giginya atau cara menggosoknya?
Berawal dari plak
Sejumlah penelitian menunjukkan, biang kerok penyebab beberapa masalah yang menimpa rongga mulut itu tak tahunya dental plaque atau plak gigi. Berupa lapisan tipis bening yang menempel pada permukaan gigi, terkadang juga ditemukan pada gusi dan lidah. Lapisan itu tidak lain kumpulan sisa makanan, dan biasanya ditemani segelintir bakteri dan sejumlah protein dari air ludah.
Celakanya, plak selalu ngendon di dalam mulut karena bisa terbentuk setiap saat. Ia akan hilang setelah dibersihkan secara mekanik dengan cara menggosok gigi. Akan makin bersih kalau dilanjutkan dengan menggunakan benang gigi.
Bila dibiarkan saja, plak yang menumpuk akan mengalami kalsifikasi, lalu mengeras. Ujung-ujungnya, terbentuklah karang gigi atau calculus yang keras dan melekat erat pada leher gigi. Itulah sebabnya gigi pada bagian itu berwarna kehitaman, kecokelatan, atau kehijauan.
Gangguan yang ditimbulkan oleh karang gigi biasanya lebih parah. Jika dibiarkan menumpuk, karang gigi dapat meresorbsi (menyerap) tulang alveolar penyangga gigi. Akibatnya jelas, gigi menjadi goyang.
Karena tampak oleh mata telanjang dan berhubungan dengan kosmetik, karang gigi lebih sering mencuri perhatian. Sayangnya, kita tidak bisa mengatasinya sendiri. Perlu bantuan dokter gigi untuk menghilangkannya dengan cara scaling. Artinya, ya membuang karang gigi.
Bakteri-bakteri seperti Streptococcus mutans dan Streptococcus sanguine yang pada keadaan normal memang berada di dalam rongga mulut - juga menimbulkan persoalan. Ketika gerombolan bakteri itu bertemu dengan sisa makanan (khususnya yang mengandung gula sukrosa) berikut enzim dari saliva, akan terjadi reaksi fermentasi yang menghasilkan asam. Bila asam itu terus-menerus diproduksi, akan terjadi proses demineralisasi atau pelunakan lapisan email gigi terdekat (email bagian terluar dan terkeras dari gigi). Karena email melunak, timbullah karies atau gigi berlubang.
Kalau menemukan spot (noktah) putih atau kecokelatan pada gigi, itu pertanda awal terjadinya karies. Semakin lama noktah semakin membesar, membentuk sebuah lubang. Biasanya masih belum ada keluhan rasa sakit pada tahap ini. Namun, ketika proses demineralisasi berlanjut sampai ke lapisan gigi berikutnya, yakni dentin, timbullah rasa ngilu saat terkena rangsangan. Terang saja ngilu karena dentin memiliki pori-pori yang berhubungan dengan jaringan saraf gigi.
Plak pada jaringan gusi yang tidak dibersihkan secara teratur juga dapat mengiritasi gusi sehingga gusi menjadi merah, mudah berdarah, dan terkadang membengkak. Ini gejala awal terjadinya gingivitis (radang gusi). Namun, karena terkadang tidak disertai rasa sakit, gejala itu luput dari perhatian dan cenderung dibiarkan saja. Bila radang gusi terus dibiarkan, gigi bisa goyang, dan akhirnya copot sendiri.
Kalau gigi sensitif
* Bisa terjadi, gigi kita tidak berlubang, tetapi ketika menenggak minuman dingin atau panas, mengunyah makanan manis atau asam, tiba-tiba gigi terasa ngilu. Kalau itu yang terjadi, mungkin gigi kita sensitif.
Ada beragam penyebab gigi sering terasa ngilu bila terkena rangsangan suhu atau rasa. Di antaranya karena terjadi abrasi pada leher gigi atau turunnya gusi (retraksi ginggiva) yang menyebabkan akar gigi terbuka. Gigi terabrasi atau gusi turun biasanya akibat tindakan kita sendiri yang kurang tepat. Umpamanya, cara menggosok gigi yang tidak benar atau memakai sikat gigi yang terlalu keras bulunya.
Gigi sensitif bisa pula akibat terkikisnya email gara-gara memakai pasta gigi yang mengandung bahan bersifat terlalu abrasif. Karena email tererosi, dentin menjadi terbuka, tidak terlindung. Akibatnya, gigi menjadi sensitif bila terkena rangsangan.
Usia tua juga bisa menyebabkan gigi sensitif, gara-gara retraksi (penurunan) gusi yang terjadi secara fisiologis. Gigi sensitif bisa pula timbul setelah dilakukan scaling. Pada saat itu akar gigi terekspos, sehingga peka terhadap rangsangan. Namun, pada kasus ini biasanya rasa ngilu akan hilang dengan sendirinya begitu gusi menutup kembali.
Apabila gigi terasa ngilu jika ujung kuku kita menyentuh daerah leher gigi dan di situ terdapat cekungan yang cukup dalam, itu pertanda terjadi abrasi yang sudah cukup dalam. Inilah saatnya untuk berkonsultasi dengan dokter gigi guna perawatan selanjutnya. Namun, jika belum terdapat cekungan, segera saja ganti sikat gigi dengan yang lebih lunak. Selain itu, perbaiki teknik dalam menggosok gigi, dan gunakan pasta gigi khusus untuk gigi sensitif.
Biasanya, pasta gigi khusus untuk gigi sensitif mengandung sodium monofluorofosfat atau strontium klorida. Menurut penelitian, kedua bahan itu akan membantu menutup pori-pori dentin yang terbuka sehingga melindungi jaringan saraf dari rangsangan suhu maupun rasa. Efeknya baru terasa setelah beberapa saat pemakaian, dan khasiatnya akan berakhir bila pemakaian dihentikan. Maka pemakaian teratur pasta gigi khusus untuk gigi sensitif ini sangat dianjurkan.
Makanan yang bersifat asam, seperti minuman bersoda dan makanan masam, sebaiknya dihindari. Kandungan asam akan turut meningkatkan suasana asam yang akan mengikis bahan pelindung yang menutup pori-pori dentin.
MENGATASI BAU MULUT
* Pernah dengar istilah halitosis? Ya, itulah nama lain bau mulut.
Bau mulut merupakan hasil metabolisme kuman rongga mulut dan sisa-sisa makanan, yang berupa gas yang disebut volatile sulfur compound (VSCs). Gas ini terdiri atas zat hidrogen sulfid, metil mercaptan, dimetil disulfid, dan dimetil sulfid. Zat-zat tersebut selalu dihasilkan dalam proses metabolisme dari bakteri atau flora normal rongga mulut. Jadi VSCs dalam keadaan normal pasti ada pada rongga mulut semua orang.
Namun, dia akan menjadi masalah ketika terjadi peningkatan kadar VSCs di dalam mulut, yakni ketika ada peningkatan aktivitas bakteri anaerob di dalam mulut yang menyebabkan bau dari VSCs ini akan tercium oleh indera penciuman. Peningkatan aktivitas itu bisa karena rendahnya kadar oksigen di dalam rongga mulut yaitu saat produksi saliva atau air liur menurun, bisa juga karena adanya karang gigi atau gigi berlubang (karies).
Cara mengatasinya antara lain:
* Jagalah kesehatan dan kebersihan gigi dan mulut dengan menggosok gigi dua kali sehari, pagi dan malam sebelum tidur.
* Jangan lupa sikatlah juga lidah Anda, karena permukaan lidah yang tidak rata memungkinkan adanya sisa makanan tersangkut di sana.
* Usahakan sesering mungkin mengonsumsi air putih, tetapi hindari minum kopi karena akan memperparah keadaan.
* Mengunyah permen karet yang sweetless atau yang tidak mengandung gula juga bisa membantu untuk merangsang produksi saliva, terutama bagi mereka yang memiliki saliva kental.
* Mengunjungi dokter gigi Anda. Mungkin ada gigi yang berlubang atau ada karang gigi.
Langganan:
Postingan (Atom)